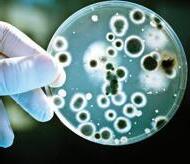

Asian Seabass in Bangladesh and Thailand
Future Proofing Shrimp Aquaculture in Asia
Shrimp Nursery Phase in India: A Panacea?
The Giant Freshwater Prawn in Asia



Asian Seabass in Bangladesh and Thailand
Future Proofing Shrimp Aquaculture in Asia
Shrimp Nursery Phase in India: A Panacea?
The Giant Freshwater Prawn in Asia




, a complete range of quality fish feeds are formulated by our experienced aquatic animal nutritionists covers freshwater and marine species. The quality diets will maximize feed intake and improving feed conversion ratio, promotes performance by supplying a specific amino acid balance to deliver excellent growth and reducing environmental impacts.







From the editor
2 Where is our finfish industry today?
Industry News
4 At Aqua India 2024, improving efficiencies, enhancing opportunities
Shrimp Aquaculture
8 Is a nursery phase a panacea?
Some critical observations from experiences with Penaeus vannamei in India by Surendran V, Ravikumar Y, Chandrasekhar JYR, Anantheswara Bhat D
13 Future proofing for sustainable shrimp aquaculture
Report on data driven strategies and quality assurance at TARS 2023
18 Inhibiting black spot and preserving freshness with a sulphite-free additive in shrimp harvests
Daniel Gilaranz describes trials to enhance microbial control and quality in farmed and wild shrimp
Disease Management
21 New generation yeast derivative supports overall immunity and enhances production performance in juvenile whiteleg shrimp
A proven efficacy on the infectious and non-infectious arm of the natural defences says Stéphane Ralite
24 More on the fine mechanisms of action of a new prophylactic feed solution to clarify its impact on EHP
Stephane Frouel, Jérémie Potier and Maxime Hugonin discuss how the induction of a specific alteration of EHP spore membrane leads to a disruption in the infection cycle
27 Shrimp diseases and mitigation strategies in India
Interview

29 Insights on steering through disease challenges in Indian shrimp farming
Ramraj Dhamodaraswamy expects industry to remain resilient despite the existential threat of diseases
Feed Technology
31 Feed forward: Feed, mycotoxins and beyond Addressing feed related issues at TARS 2023
36 Power of Nutrition: Back to basics and postbiotics for gut health Part 2 on dsm-firmenich’s 28th Aqua Conference Asia Pacific
41 Shrimp feed palatability and feed consumption
Dean M Akiyama says that actual palatability of shrimp feeds is related to consumption levels in production ponds during operations
Industry Review - Marine Fish
44 The first steps in bringing Asian seabass farming culture into Bangladesh
Md Modabbir Ahmed Khandaker relates his recent success at Greenhouse Mariculture to supply homegrown 1.76g fingerlings
47 A success story on Thai earthen pond seabass farming
Soraphat Panakorn meets Suthi Mahaloa at Boonsawang farm who says that a mark of success is when his fish is accepted by Japanese chefs in Bangkok.
50 Future of ocean aquaculture with satellite remote sensing
A Q&A with UMITRON’s Ken Fujiwara on his aspirations for remote sensing Book

It is so easy to be caught-up with the shrimp farming industry which is estimated to be worth over USD60 billion. The Asian finfish industry comprises the tilapia, pangasius and several species of marine fish which may seem small individually but when aggregated, can easily match the value of shrimp and yet, it is often overlooked. As a seafood and source of protein, aquaculture must build more sectors which can provide export commodities, drive the economy, create employment and contribute to food security.
So where is our finfish industry today? Here we review each sector from the perspective of a SWOT analysis.
Global tilapia production has exceeded 6.5 million tonnes annually. China and Indonesia are the top two producers contributing 1.75 million tonnes and 1.57 million tonnes respectively. Tilapia was a backyard species 50 years ago which contributed to the local community’s food protein
We strive to be the beacon for the regional aquaculture industry.
We will be the window to the world for Asia-Pacific aquaculture producers and a door to the market for international suppliers.
We strive to be the forum for the development of self-regulation in the Industry.
basket but today, it has transformed into a major export commodity with a strong market in the US, reaching the number 4 spot with 1.04 pounds per capita consumption. Tilapia is a versatile fish which can be cultured in most tropical countries all around the world. It can be grown to smaller sizes to match the buying power of local communities (think of Egypt) or larger sizes to be filleted and processed for the export market. However, as an export commodity, its marketing and branding is still weak. Regal Springs is a role model in lifting the tilapia out the perception of a poor man’s fish. Opportunities lie in cage culture in clean waters which removes the ‘offflavour’ generally associated with this fish. Genetic selection has also developed marine tolerant fish which cultured in seawater, has a ‘sweeter’ taste. The threat comes from tariff barriers such as US’ section 301 which carries a 25% duty on China origin tilapia.
Vietnam’s pangasius exports for YTD October 2023 is valued at USD 1.52 billion coming from 1.34 million tonnes of production. The major importers are China (32%) and the US (15%), respectively. This is impressive as this single species is a major export revenue earner for the country. The largest integrated enterprise - Vinh Hoan, ranks as one of the country’s top agricultural companies and the industry, including its support sectors, provides significant employment in the Mekong Delta. There is no generic marketing for this product, and it still sits at the bottom of the ‘whitefish ladder’ price-wise. Without creating more global demand, Vietnam’s pangasius production stagnates at about 1.6 million tonnes above which, the price is negatively affected. The opportunity comes from the ‘farmed fish complex’ where co-products such as fishmeal, oil and collagen are equally large income earners providing better margins than fish fillets for human consumption.
The marine fish industry is the ‘third leg’ to stand-on but it is a multi-species business today. Consequently, it is the major weakness in that resources are spread widely and thinly. The industry needs to focus on one species at a time to build its supply chain with support services from genetics, hatchery-nursery, feed and processing. The Asian seabass or barramundi shows the greatest promise as it is the “first horse out of the gate”. Australis, Vietnam and Phillips Seafood, Indonesia are already building integrated operations with credible branding and marketing. The opportunities and threats seem to mirror each other. Due to the high prices for live marine fish, there is little incentive to grow larger sizes for processing and expansion into export markets. The current business model is its own biggest enemy as the current margins allow for low survival rates and inefficiency, resulting in the industry being stuck in mediocrity. For the fish to grow to larger sizes, the biggest challenge is disease mitigation and here, vaccine companies must weigh the business potential as many are reluctant to enter this relatively small and unattractive market. Hence, we have a ‘chicken and egg’ situation.
With these issues, where do we start? While there are large and successful integrated operations making waves globally, most stakeholders in Asia are still seeking directions for growth. The simple answer is to prioritise and focus and this is the key driver for -The Aquaculture Roundtable Series- TARS 2024 – Finfish Aquaculture: Steering an Industry into Focus.

If you have any comments, please email: zuridah@aquaasiapac.com






In 2024, the Society of Aquaculture Professionals (SAP) celebrates its 20th anniversary and at this 12th AquaIndia, past presidents gave short perspectives on how the event has changed together with that of the industry. Aqua India started in Nellore, Andhra Pradesh, the centre of shrimp farming. S Santhan Krishnan (middle right) remembered the first conference with 200 participants and just a projector while Ravi Kumar Yellanki (left) stressed that the problem is not production but markets which is beyond the control of farmers. Other past presidents on stage are from second left, D. Ramraj, R. Srinivasan, S. Muthukaruppan and Victor Arul Suresh
Living up to expectations toward continuous improvements, India’s Society of Aquaculture Professionals (SAP) did not fail its members. This was the most interactive Aqua India, packed with discussions covering the shrimp supply chain. This 12th Aqua India 2024 which coincided with the 20th anniversary of SAP, was held from February 15-17 in Chennai.
India is the largest global shrimp producer after Ecuador. There are no constraints on production, but doom and gloom pervaded industry stakeholders with the current oversupply and low prices. A large domestic market will help absorb a portion of its production and relieve the global shrimp supply situation. The question was how to develop a domestic market. SAP assumes that 100,000 tonnes is consumed in domestic markets. However, leaders in India’s farmed shrimp industry often cited that if only a small portion of the 1.4 billion population can consume a mere 0.5 kg annually. The good news is that in recent years, larger farm owners are now venturing to retail markets for their shrimp. A wish is to “produce like Ecuador and consume shrimp locally like China”.
India has had a fast trajectory in vannamei shrimp production, which has been regulated via stocking density at 60 PL/m2 imposed by the Coastal Aquaculture Authority. Now farmers practice self-regulation in reducing stocking density further to have better prices and disease control. In the case of vannamei shrimp, it was already announced that farmers stocked less in 2023, beginning from the second crop. While farmgate prices are low, costs of production (COP) have increased, from
rising costs of feed inputs, increases in minimum wages for the industry and higher energy costs. The Andhra Pradesh government has revised energy costs recently. Stocking density has gone down to 40 PL/m2. According to Ravi Kumar Yellanki, when prices are down, farmers cannot go for intensification which raises the cost of production.
SAP President Madhusudhan Reddy announced that the final estimate of production in 2023 was 850,000 tonnes, comprising 700,000 vannamei shrimp and only 39,000 tonnes of monodon shrimp. The three top producers were Andhra Pradesh at 640,000 tonnes (78%) followed by Odisha, 54,200 tonnes (6.6%) and West Bengal at 50,000 tonnes (6.1%). In the case of the monodon shrimp, Andhra Pradesh produced 24,000 tonnes (61%) and Gujarat, 15,000 tonnes (39%). Industry used 85 billion vannamei post larvae in 2023.
Reddy mentioned some challenges during the vannamei crop cycle. Diseases included white spot syndrome virus (WSSV), white faeces syndrome (WFS), Enterocytozoon hepatopenaei (EHP) and running mortality syndrome (RMS). Challenging too were unstable and fluctuating prices, limited cash flow, increasing costs of inputs and unpredictable weather with rains and cyclones. In the hatchery segment, a challenge was excess production capacity as farmers stocked less post larvae and stocking trends were unpredictable. Added to the problem was a change in farmers’ preferences for broodstock lines.

The outlook for 2024 remains positive despite a slow start for the first season. Industry expects an increase in production in the next season and better output from expansion of farming areas in the north of India and parts of Andhra Pradesh with lower lease rates. There is also talk on species diversification and CIBA is working on the domestication of the native Penaeus indicus.
The keynote speaker at the event, Dr Francisco Gomes , Founding Partner, and CIO at Ocean 14 Capital noted that implementation of intensive sustainable production systems is hampered by industrial misalignments where the drive in genetics, health and nutrition is more aligned with industrial needs. He said that the lack of financial profitability and training, high capex, as well as high energy requirements are the reasons for the misalignment.
Gomes described OC14’s PHT platform and demonstrated the impact of SyAqua with inputs on genetics, nutrition, data collection and automation. “Shrimp as an industry does not generate knowledge fast enough. We need to accelerate knowledge creation collectively.” Gomes explained that knowledge creation should follow the SECI model which explains the movement of tacit and explicit knowledge via socialisation, externalisation, internalisation and combination.
What was trending in the global shrimp market while focussing on India’s contribution was highlighted by Willem van der Pijl , Shrimp Insights. In 2022-2023, India increased exports while there were declines in exports from Vietnam and Indonesia. Meanwhile, importing markets - US, EU and Japan, reduced imports by 6%, 8% and 12% respectively. The only market with rising imports was China, at +30%.He added that the elephant in the room is Ecuador - with increased production, estimated at 14% in 2023, with 1.5 million tonnes of production and 1.2 million tonnes of exports. As for India, if December figures for 2023 are on par with that in 2022, its exports would be 714,572 tonnes.
Van der Pijl also made some suggestions on how Indian producers can maintain and expand markets. “In the raw and frozen vannamei market, India remains the largest in the US peeled segment. In the EU, India could still gain market share from other suppliers if size and other
requirements can be met. Growth is expected in the value-added markets and India should benefit from it by building up capacity.”
Ecuador’s reputation with head-on shrimp comes from attention on post-harvest quality. Jorge Sanabria , Grupo Nueva Pescanova, outlined some practices which result in poor shrimp quality such as with melanosis. The key area is to focus on the production of quality head-on shrimp from India. He asked: while farmers are diligently taking care of the biomass in the pond, why do they neglect taking care of the shrimp after harvesting?
There was a lineup of panels focussing on the various areas in vannamei production: improvement in efficiency in production at the pond level; crop rotation; and benefits of nurseries to various feeding management strategies. A session looked at monodon shrimp farming with the availability of specific pathogen free (SPF) post larvae. A report on the panel discussing disease mitigation is given on pages 27-28.
Dr Saji Chacko , Partner Poseidon Enterprises, led a panel that discussed pond preparation and cropping patterns. Dr Pornlerd Chanratchakool , Novonesis Aqua team, Thailand, emphasised on the need to go back to basics, invest in pond preparation and reduce input costs. In discussing the complexities involved in pond preparation especially in vannamei shrimp farming, he said, “Unfortunately, there is a tendency to maintain a continuous crop.”
Crop holidays are common because of low prices. A group of farmers stopped operating in March and resumed in April to June. This is possible at the village level but state wise, it may be difficult to implement as supply must continue. In West Godavari, rotation with Indian major carps resulted in a better shrimp crop. In Gujarat, when the farm failed to get even 5 tonnes of vannamei, a change to monodon shrimp culture yielded a 10-tonne harvest.
Chacko’s take home message was, “We must have good pond preparation, and plan the crop in such a way that the stocking is staggered. Multiple harvests done at different sizes and having a break in the crop cycle should be adopted. This is the mantra to improved efficiencies.”
It was a sharing of experiences with a nursery phase at the panel titled, “Nursery and Beyond” led by S Chandrasekar , USSEC’s Head Aquaculture Utilisation, South Asia. In India, the target is to have robust post larvae, compensatory growth and EHP mitigation.



Around Asia, there are various versions of 3-phase shrimp farming such as 2-phase hatchery and growout in Indonesia and hatchery reared post larvae and 2-phase grow-out in Thailand. Surendran V , Vaisakhi Bio-Marine, presented on nursery development at a 25-year-old farm with a high success rate (See article on pp8-12). He explained that nursery is not a panacea but a technical tool. Opinions were on compensatory growth which young farmer Nishanth Reddy saw less of this in his multiphase production system in Ongole which also uses biofloc technology.
With the current situation with volatile yet low prices, caused by oversupply and low demand, there is no question that boosting demand for shrimp is important. In 2023, the Global Shrimp Forum Foundation had commissioned a report on how to promote the consumption of shrimp around the world. The author of the report, Arnd Jan Gulmans was in Chennai to present some details such as how to identify the biggest opportunities for growth and what can we tell people about shrimp to make them eat more shrimp.
In the session on India’s shrimp market potential, emphasis was on enhancing opportunities in the domestic market. Almost 70% of the Indian population are nonvegetarians and shrimp is considered a food for special and festive occasions. Sharat Reddy , Sharat Industries, said that although India is a major producer, there is little effort to spread awareness on shrimp within the country. There is a massive opportunity for a domestic market especially since in recent years, cold supply chains have improved. It is important that consumers understand that frozen shrimp is as good as fresh products. The future is value addition to attract the younger population.
Balasubramaniam V , President of the Prawn Farmers Federation of India explained the action plan to create a substantial domestic market with a seamless distribution network to push large volumes of shrimp across India. He added that with the current situation, at the mercy of international buyers, some farmers are losing INR50/kg, when products are exported to China.
The association wants to ensure consistent availability, quality, and pricing of shrimp. The pilot project is to set up 10 farmer organisations by the corporate style shrimp producers in Andhra Pradesh. These will sell 100 tonnes of shrimp per day and 30,000 tonnes per annum. There will be central processing hubs and satellite distribution centres. “This is to promote supplies direct from farms and ensuring superior freshness and products with no soaking and eliminating middlemen to reduce costs and maintain affordable, stable prices.”
Priyanka Mohanty , Director at Falcon Group, one of the leading seafood exporters in the country gave the “Falcon Chilika Fresh” story as part of its domestic marketing strategy. Since 2018, it has planned 26 stores in Odisha but started only 12 stores. The idea is to make these stores single stop solution with a range of products, just like the street vendors. “We had to create awareness on the benefits - health and nutritional. This was most difficult. We used social media.”
The challenges include fighting consumer perception on price because stores are air conditioned and therefore products are perceived to be costly. Priyanka said that profitability can be achieved with higher volumes and the way forward is to focus on B2B segment (horeca). It is also to create mass awareness and enhance the reach of online platforms.

A synergistic alliance of inactivated yeast fractions
• Synergistic effect confers broad and balanced immune response (patented*).

• Supports skin mucus excretion and skin healing capacity.
• Mitigates the risks associated with transfers, speeds-up recovery.
The best defense lies in working together.

*The patent status of the described invention may vary by country.
Partnering in microbial solutions for a changing world.
Using sound science, proven results and knowledge from experience, Lallemand Animal Nutrition helps our customers and industry partners be more successful – and animals lead healthier lives.
Lallemand Animal Nutrition provides a full range of specific, natural microbial products, services and solutions that improve animal well-being and performance while respecting animals, people and the environment.
yeast association new generationfollows: If area is 100ha and success is only in 90 ha.(i.e. with a harvest of 10g or above ABW), then the % successful ponds by area is 90/100 = 90%. Therefore %success could be calculated as 80%*90% = 72%.
Some critical observations from experiences with Penaeus vannamei in India
By Surendran V, Ravikumar Y, Chandrasekhar JYR and Anantheswara Bhat D
Shrimp farmers in India have been experimenting with the concept of a nursery phase, so as to utilise larger nurseryreared post larvae (PL30 - PL50) or 0.2 to 2.0g juveniles for stocking in their ponds and expecting better results with this practice. However, results have been mixed, with farmers experiencing failures during the nursery phase. In this article, we analyse the benefits or otherwise for a farmer, particularly of a small-scale farm equipped with a nursery phase.
As observed, using nursery reared PL, since the eighth crop, the success rate in terms of successful pond runs has improved However, the rate of success did not remain at 100% level, though it was better compared to those days when we did not have nursery facility. With other variables (such as prevalence of white spot syndrome virus (WSSV), Enterocytozoon hepatopenaei (EHP), white gut, and non-conducive climatic conditions), a nursery phase, though helpful, is not a panacea; it did not solve all the problems, although it helped
area is 100ha and success is only in 90 ha.(i.e. with a harvest of 10g or above ABW), then the % successful ponds by area is 90/100 = 90%. Therefore %success could be calculated as 80%*90% = 72%.
As observed, using nursery reared PL, since the eighth crop, the success rate in terms of successful pond runs has improved. However, the rate of success did not remain at 100% level, although it was better compared to those days when we did not have a nursery facility. With other variables, such as prevalence of white spot syndrome virus (WSSV), Enterocytozoon hepatopenaei (EHP), white gut, and nonconducive climatic conditions), a nursery phase, while helpful, is not a panacea; it did not solve all the problems.
In addition to a better success rate, some other benefits in the grow-out phase in lieu of using nursery reared PL were improved survival (Figure 2) and increased growth rate (Figure 3).
Technical operations of a farm-based, pond-type nursery system are already standardised in India (Surendran et al. 2019). Browdy et al. (2016) observed that nurseries typically involve lined tanks/ponds covered by plastic greenhouses or roofs suspended by cables. Refinements in shrimp nursery technology and the need to maintain profitability of operations will likely result in increased use of this strategy in farms located in tropical regions (Jory, 1997).
From a farmer’s perspective, biosecurity, stocking density and survival are three factors connected to the concept of nursery phase and in farm management of P. vannamei. Below we detail our experiences and observations with our shrimp farm project in Tuni, near Visakhapatnam (also known as Vizag), Andhra Pradesh, on the east coast of India.
Ten years ago, we bought an old shrimp farm, which was almost a quarter century old. Since then, we have been farming shrimp here and currently we are into the 18th crop.
Sometime around the eighth crop, we commissioned a farm-based pond-type nursery in our facility, to cater to our in-house demand of large post larvae (PL). Nursery PL were reared for about a month before they were introduced into our grow-out system. Following this, it has been a practice to stock nursery-reared PL either completely or partially in our grow-out ponds. Figure 1 shows our rate of success in grow-out operations over the last 17 crops. Here % success is calculated as relative yield x % successful ponds (in hectare or by area). Relative yield is explained as follows: if the target yield is 7.5 tonnes but harvest is only 6 tonnes (yield), the relative yield is 6/7.5= 80%. Percent successful ponds by area could be explained as follows: If
In addition to a better success rate, some other benefits during grow-out when using nursery reared PL were improved survival (Figure 2) and increased growth rate (Figure 3).
An increase in % survival from 78% (direct stocking) to 93 % (stocked from nursery) was observed in grow-out ponds. Similarly, the average daily growth (ADG) of 0.2g was observed around 100 days of culture (DOC 100) in ponds stocked from nursery, whereas ADG was at around 0.15g at the same DOC in directly stocked ponds.









However, if we recalculate the ADG over the whole culture cycle (time in nursery and time in grow-out ponds) the ADG was around 0.15g only. In other words, we could not observe any significant compensatory growth in the ponds. However, during an outbreak of WSSV, a nursery phase will give us the advantage of 20 days. With the increased growth rate, we could get a harvest of 10g (ABW) shrimp. This is the minimum marketable size that processors will accept and hence to breakeven (Figure 4).
From a farmer’s perspective, biosecurity, stocking density and survival are the three core points.
From a farmer’s perspective, biosecurity, stocking density and survi the three core points.

The good news on biosecurity is that we can mitigate WSSV and EHP incidents in small, lined ponds that are covered on all sides. The bad news is that it is difficult to fully control both WSSV and EHP in large, earthen ponds in spite of all possible efforts on biosecurity and pond preparation.
Our take-home message from these observations is: If we can afford this kind of superior infrastructure in lined ponds, then perhaps a nursery phase will probably not be essential. On the contrary, in less biosecure systems, a nursery phase would be beneficial; the 20–30 days’ advantage in terms of growth, will help the farmer with better economics (Figure 4).
The on biosecurity is that we can mitigate WSSV and EHP incidents in small, lined ponds that are covered on all sides (Figure bad news difficult to fully control both WSSV and EHP in earthen ponds in spite of all possible attempts on biosecurity pond

Average daily growth (ADG) was observed to be conspicuously varied as shown in Figure 5 with different stocking densities viz. 0.15g (at 50PL/m²), 0.25g (at 25PL/ m²) and 0.32g (at 18PL/m²). As the growth rate at a stocking density of 25PL/m² and below was higher than the growth rate with nursery phase (0.20g in higher stocking densities of 40PL/m²), for such low densities, farmers could probably 4
Grow-out: Small, lined ponds that are covered on all sides.

Our take-home message from these observations is: If we can afford this kind of superior infrastructure in lined ponds, then perhaps a nursery phase will probably not be essential. On the contrary, in less biosecure systems, a nursery phase would be beneficial; the 20–30 days’ advantage in terms of growth, will help the farmer with better economics (Figure 4).
Stocking density
do without a nursery phase and proceed with direct stocking of hatchery PL. Whereas for stocking densities of 40PL/m2 and above, there could be an advantage of a nursery phase with an expected ADG of 0.20g compared to an ADG of 0.15g with direct stocking of hatchery PL.
Average daily growth (ADG) was observed to be conspicuously varied as shown in Figure 7 with different stocking densities viz. 0.15g.(at 50PL/m²), 0.25g.(at 25PL/m²) and 0.32g (at 18PL/m²). As the growth rate at stocking density of 25PL/m² and below was higher than the growth rate with nursery phase (0.20g in higher stocking densities of 40PL/m² for instance), for such low densities, farmers could probably do without a nursery phase and proceed with direct stocking of hatchery seeds. Whereas for stocking densities of 40PL/m2 and above, there could be positive influence with nursery phase with an expected ADG of 0.20g compared to an ADG of 0.15g only with direct stocking of hatchery PL.
Running mortality syndrome (RMS) was observed to be more prominent after DOC 90 in grow-out ponds; a twenty-point drop from 95 to 75% or more was observed (Figure 6) from DOC 90 to DOC 120. The farmer has to be extra cautious with regard to feeding and shrimp biomass in this context. The gain in ABW of shrimp was offset by a reduction in survival rate.

Figure
A take-home message here is that the nursery phase would enable the farmer to harvest a crop by DOC 90, without the risk of a 4th month of grow-out. A nursery helps in this regard with better ABW in the grow-out pond (18g) compared to 13.5g only with directly stocked PL from the hatchery by DOC 90 (with an ADG of 0.20g) compared to direct stocking (Figure 7).
The advantages of having a nursery phase are well documented (Surendran et al. 2019) – these include both technical and managerial advantages. Technical advantages include higher success rate, increased survival, better growth and improved biosecurity. Managerial benefits include efficient utilisation of resources such as space and time, improved efficiency in operations and cost control. For small-scale farmers, however, their concerns are the challenges involved in nursery operations.



References
Browdy, C., Van Wyk, P., Stock, C., Thomas R. Zeigler, T.R., Lee, R. , 2016. Shrimp nursery technology: System design and management for cost-effective results Part 1. Design considerations. Aqua Culture Asia Pacific, March/April 2016 pp 39-43.
Browdy, C., Van Wyk, P., Stock, C., Thomas R. Zeigler, T.R., Lee, R., 2016. Shrimp nursery technology: System design and management for cost-effective results Part 2. Water quality, biofloc technology, feeds and feed management. Aqua Culture Asia Pacific, May/June 2016 pp 25-30.
Jory, D.E., 1997. Penaeid shrimp nursery systems. Aquaculture, 23 (2): 95-103.
Surendran V, Ravikumar Y, Chandrasekhar JYR and Anantheswara
Bhat D. 2019 Experiences at a farm-based, pond-type Penaeus vannamei nursery in India. Part 1: A general description of the overall nursery concept, success criteria and investment costs. Aqua Culture Asia Pacific, September/October 2019, pp8-14.
https://bitly.ws/3f6iz
Surendran V, Ravikumar Y, Chandrasekhar JYR and Anantheswara Bhat D. 2019. Experiences at a farm-based, pond-type Penaeus vannamei nursery in India. Part 2: Nursery operations from pond preparation, water and feed management to transfer of juveniles to ponds. Aqua Culture Asia Pacific, November/December 2019, pp19-23. https://bitly.ws/3f6hY
Advantages of a nursery phase
These are:
The advantages of having a nursery phase are well documented (Surendran et al. 2019) – these include both technical and managerial advantages. Technical advantages include higher success rate, increased survival, better growth and improved biosecurity. Managerial benefits include efficient utilisation of resources such as space and time, improved efficiency in operations and cost control. For the small farmers, however, their concerns are the challenges involved in nursery operations.
• High capital cost of building a nursery system (minimum INR1,500,000 or USD18,000 per 0.1ha), excluding land cost.
• Increased operational costs (cost of PL increases by around 35 paise (USD4,216/million PL).
Challenges in nursery operations
The main challenges are:
• Increased cost of harvest (approx.10 paise per PL (USD1,204/million PL) and risk involved in harvest.
• Biosecurity risks in nursery operations.

Surendran V, Director-Technical has more than 36 years of technical project management experience, particularly in hatchery and farm management. Email: surendran2006@gmail.com
Chandrashekhar JYR is Executive Director and holds a Civil Engineering degree.
• Compensatory growth is not guaranteed.
• High capital cost of building a nursery system (minimum INR1,500,000 or USD18,000 per 0.1ha), excluding land cost.
• Risk of failures (stock loss, infections etc.,).
•Increased operational cost (cost of PL increases by around 35 paise (USD4,216/million PL).
Conclusion
We conclude that a nursery system is not a panacea, i.e., it does not solve all the problems. However, it does help as a technical and managerial tool and is useful if the stocking density is high in the grow-out ponds such as 40 PL/m2
8

For lower stocking densities in the grow-out ponds, such as below 25 PL/m2, direct stocking of hatchery-reared PL probably is good enough. The growth rate is better in this case compared to nursery reared PL stocked at higher density in grow-out ponds (>40 PL/m2).
A nursery is an advantage when farms can afford the capital investment and operational cost and have the technical know-how.


Ravikumar Y is Managing Director and holds a Civil Engineering degree from Nagarjuna University and a postgraduate diploma in management from Xavier Institute of Management. Email:yelra@rediffmail.com
Anantheswara Bhat D is Executive Director and holds MSc degree in Marine Biology.
All authors are with Vaisakhi Bio-Marine (P) Ltd., Visakhapatnam, India.
Industry stakeholders must prepare for the future of sustainable shrimp aquaculture. Regis F. Bador , Development Strategy Advisor, New Caledonia, moderated the panel on “Future proofing Asia’s Shrimp Aquaculture” and explained, “The concept of future proofing is the process of anticipating the future and developing methods of minimising the effects of shocks and stresses of future events.”
The challenge for the five speakers was to focus on strategies to future proof shrimp aquaculture in Asia. These included the areas of farming, production cost, product quality for markets, pathogen control, smart feeding technology and life cycle analysis (LCAs).
“The industry experienced robust growth from 2021 to 2022; farmed shrimp production grew ±11% while market demand was ±13%,” said Herve Lucien-Brun, Aquaculture Consultant, Jefo Nutrition as he gave an overview of headwinds facing the industry in 2023. “As supply increases, various factors are causing disruptions in key markets, particularly in China, the EU, US, and Southeast Asia.”
“Demand has been affected by inflation, consumer confidence and economic woes, impacting market stability and farm-gate prices,” added Lucien-Brun. “While global supply increases, market demand struggles to keep pace, resulting in falling prices and reduced profitability for shrimp farmers. In this competitive environment, while larger enterprises benefit from economies of scale and market expertise, small independent producers face significant challenges,”.
Energy and fuel costs, as well as feed costs continue to rise. In 2023, energy and fuel costs were 7%, 20% and 13% of cost of production (COP) in Ecuador, Thailand and Indonesia, respectively. “Intensification, often involving increased aeration to maintain dissolved oxygen levels, poses a critical challenge: Will increased production compensate for the extra energy costs?” asked LucienBrun. In Vietnam, the impact of falling farmgate prices was dire. Wei Che Wen Uni-President Vietnam, noted that in 2023, the average cost of production in Vietnam was USD3.5~4.5/kg (50/kg)while farmgate prices were USD4.0-5.0/kg.
Feeds account for more than 50% of COP, such as 53% in Ecuador, 42% in Thailand and 56% in Vietnam. Shrimp feed prices have escalated in tandem with increasing prices of the major ingredients. However, the cue from the presentation by Dominique Bureau, is that more can be achieved by smart feed management. “Productivity and profitability are often negatively affected by poor feeding management.”
“What are we not seeing with standard farming practices is with regards to microbiomes and hence affecting our inability to make decisions around preventative shrimp farm management,” said Alex Farthing, Co-founder and
Chief Scientific Officer at Indonesia-based Delos Aqua.
The company focusses on enterprise farm management. In his presentation, he covered some aspects of the health work stream and explored techniques and technologies to unlock the story on the microbiome in shrimp gut and provide health insights. “Microbiome management has emerged as a developing aspect of shrimp farming, aiming to enhance health, productivity, and sustainability within aquaculture systems,” said Farthing.
Conventional methods like plate count and flow cytometry face limitations in accurately capturing the microbial

Alex Farthing said, “Colonisation of beneficial microbiota, ideally initiated in broodstock and maintained throughout hatchery and grow-out phases, is essential for effective microbiome modulation.”

The Hydrotech Drum Filter Value series focuses on reduced maintenance, increased component quality and simplified operation – all to give your plant maximum filtration performance at a minimum operational cost.
Let us help you!
Call +46 (0)40 42 95 30, or visit www.hydrotech.se
diversity and dynamics within shrimp farms. Metagenomic analysis is a promising tool, offering deeper insights into microbial changes and disease correlations to facilitate early intervention and disease management. Farthing said, “Significant mortality with an EHP infection can be correlated with high vibrios. Understanding the presence and makeup at this level of detail can show when we can expect mortality and how it will impact feed and how to change feed management practices.”
In cases of multi-infections like AHPND-IMNV-EHP, gut dysbiosis is correlated with shrimp mortality rates. Microbiome fingerprinting shows the composition of microbiome in gut and hepatopancreas versus that in water and sediment (Figure 1). Organelle damage is when microbiome in gut and hepatopancreas equals that in water and sediments. Therefore, understanding these dynamics is pivotal for adjusting treatment strategies and enhancing microbial balance to improve shrimp health and survival.

Figure 1.
fingerprinting
resulting in the microbiome being vulnerable to further changes.
“The survival strategies for farmers include: control production costs, adapt production to demand, optimise product quality, and consider market-appropriate certification to enhance product value,” said Lucien-Brun.
“Soybean meal, wheat flour and fishmeal are major components of feed. Dwindling supplies and rising prices mean that alternative protein sources need to be used, despite challenges in nutritional consistency and environmental impact. Therefore, there is a role for dietary proteases to enhance protein digestibility and amino acid availability, thus improving growth performance and margins in shrimp farming. Experimental studies demonstrate the effectiveness of protease inclusion in shrimp diets, offering a sustainable solution to reduce feed costs and environmental impacts. Non digestible proteins are not metabolised, and waste feed pollutes the environment”.

Farmers play a crucial role in preserving quality; it is incentivised by price differentials based on product quality, as seen in Ecuador – Herve Lucien Brun
shrimp with multi-infections (AHPND shows the microbiome in gut and hepatopancreas versus those in sediment and water.
Source: Alex Farthing, 2023. Health and Microbiome Monitoring for Preventative Shrimp Farm Management Presented at TARS 2023.
Figure 1. Microbiome fingerprinting in shrimp with multiinfections (AHPND-IMNV-EHP) shows the microbiome in gut and hepatopancreas versus those in sediment and water. Source: Alex Farthing, 2023. Health and Microbiome Monitoring for Preventative Shrimp Farm Management Presented at TARS 2023.
Promising tools in microbiome management
Promising tools in microbiome management
These include probiotics and prebiotics, offering avenues for both prophylactic and therapeutic interventions in shrimp farming. Delos has spent a lot of time and effort to prove efficacy and applications. “Probiotics, comprising a substantial portion of chemical and additive costs, are challenging to validate effectively. It forms 19-20% of our total chemical cost production, but we can see efficacy over a long period,” said Farthing
These include probiotics and prebiotics, offering avenues for both prophylactic and therapeutic interventions in shrimp farming. Delos has spent a lot of time and effort to prove efficacy and applications. “Probiotics, comprising a substantial portion of chemical and additive costs, are challenging to validate effectively. but we can see efficacy over a long period,” said Farthing.
“Metagenomic analysis indicates that despite regular Bacillus-based probiotic additions, bacterial composition often remains stagnant or decreases over time. Assessing probiotic efficacy requires considering environmental factors and delivery methods to optimise dosage and application. In the case of prebiotics, the challenge is delivery. Key criteria include resistance to gastric acid, fermentability by gut microbiota, and selective promotion of beneficial bacteria. Delivery methods, whether through diet or on-farm addition, play a role in prebiotic effectiveness,” he added
Microbiome modulation: Initiating and recovery
“Metagenomic analysis indicates that despite regular Bacillus-based probiotic additions, bacterial composition often remains stagnant or decreases over time. Assessing probiotic efficacy requires considering environmental factors and delivery methods to optimise dosage and application. In the case of prebiotics, the challenge is delivery. Delivery methods, whether through diet or onfarm addition, play a role in prebiotic effectiveness,” he added.
Microbiome modulation: Initiating and recovery
The shrimp market is diverse and complex. Differentiating products based on presentation, origin, and quality is crucial to meet consumer expectations and navigate price fluctuations effectively. Maintaining product quality from farm to market is most important, as quality degradation occurs rapidly post-harvest. Farmers play a crucial role in preserving quality; it is incentivised by price differentials based on product quality, as seen in Ecuador. Direct communication between farms and packing plants improves quality assurance and enhances consumer satisfaction. Understanding cultural and consumer preferences is essential for exporters to deliver products that are attractive to end consumers.
Colonisation of beneficial microbiota, ideally initiated in broodstock and maintained throughout hatchery and grow-out phases, is essential for effective microbiome modulation. Early intervention ensures the establishment of a healthy microbiome, which promotes shrimp health and resilience to diseases.
Colonisation of beneficial microbiota, ideally initiated in broodstock and maintained throughout hatchery and grow-out phases, is essential for effective microbiome modulation. Early intervention ensures the establishment of a healthy microbiome, which promotes shrimp health and resilience to diseases.
Certifications such as ASC, BAP, and Global GAP reassure consumers and facilitate market access. These certifications validate responsible farming practices and ensure product safety and quality throughout the supply chain. Choosing the right certification while considering regional preferences and consumer expectations is useful. Awareness of certification requirements and compliance to industry standards are necessary for market competitiveness and consumer trust.
While resilient microbiota can naturally recover to a healthy state, efficacy of therapeutic treatments on dysbiosis at a field scale remains limited. Despite gut microbiome recovery, tissue regeneration remains slow, resulting in the microbiome being vulnerable to further changes.
While resilient microbiota can naturally recover to a healthy state, efficacy of therapeutic treatments on dysbiosis at a field scale remains limited. Despite gut microbiome recovery, tissue regeneration remains slow,
In 2022, industry in Vietnam produced 950,000 tonnes of shrimp. However, success rates lingered at only 30-40%, largely due to prevalent diseases such as EMS and EHP which accounted for over 70% of problems. Small farms,
covering 1-3ha are the majority. Therefore, future growth of industry in Vietnam requires farming models which balance management and carrying capacity.
farms, covering 1-3ha formed the majority Therefore, future growth of industry in Vietnam requires farming models which balance management and carrying capacity
“First, we need to understand the concerns of these small farmers. They cannot afford large investments. To them, production cost is a major concern. We must suggest a model which will reduce their production costs. The model should be easy to operate and replicate for multiple ponds,” said Wei.
“First, we need to understand the concerns of these small farmers. They cannot afford large investments. To them, production cost is a major concern. We must suggest a model which will reduce their production costs. The model should be easy to operate and replicate for multiple ponds,” said Wei
“Since the area is small, we suggested a model with small ponds for intensive water treatment, and nursery to reduce the grow-out time in culture ponds. In such models, production can reach 20-25 tonnes/ha. We emphasise on eight control points,(Figure 2).”
Wei explained, “Since the area is small (1-3ha), we suggested a model with small ponds for intensive water treatment, and nursery to reduce the grow-out time in culture ponds. In such models, production can reach 20-25 tonnes/ha. We emphasise on eight control points,(Figure 1).”

or partial harvests to maintain optimal conditions
Figure 2. The model with small ponds. Source: Wei Che Wen, 2023. Balancing shrimp farming models with management and carrying capacity for the future growth of industry in Vietnam. Presented at TARS 2023.

methodology unique to
Source: Wei Che Wen, 2023. Balancing shrimp farming models with management and carrying capacity for the future growth of industry in Vietnam Presented at TARS 2023.
Control points
The Mekong River is the major water source, and more than 10 farms can share the same stream. Water treatment starts with a settling pond, and in treatment ponds, water undergo disinfection and filtration, with rigorous checks on parameters (pH, hardness, bacterial count, and turbidity). Vibrio is a major issue and its control to less than the maximum (103CFU/mL) in pond water can increase success rate by 30%. Application of probiotics plays a crucial role in inhibiting Vibrio growth.
The Mekong River is the major water source, and more than 10 farms can share the same stream. Water treatment starts with a settling pond, and in treatment ponds, water undergo disinfection and filtration, with rigorous checks on parameters (pH, hardness, bacterial count, and turbidity). Vibrio is a major issue and its control to less than the maximum (103CFU/mL) in pond water can increase success rate by 30% (Figure 2). Application of probiotics plays a crucial role in inhibiting Vibrio growth. There is a selection of Bacillus spp for pond water, photosynthetic bacteria for bottom and sludge shrimp gut and hepatopancreas, Lactobacillus
PIC

Wei Che Wen said that overloading carrying capacity requires strategic actions like transfers or partial harvests to maintain optimal conditions.
A common practice is to change water 40-50% per day since culture is intensive with stocking density at 150-200 PL/m2. “Since they have already built up their bacterial system, we ask farmers to reduce water exchange, check ammonia and nitrite levels and siphon to remove wastes 6 times/ day, to minimise organic buildup and shrimp mortality. Feeding practices are monitored closely to avoid overfeeding. Feeding trays are used for accuracy.”
An important criterion is biomass control. Farmers are advised on carrying capacity and recommendations are based on pond types. Overloading requires strategic actions like transfers or partial harvests to maintain optimal conditions. “In our model, we recommend a maximum of 2~2.5kg/m3 in lined and round tanks and maximum 1~1.5 kg/m3 in earthen ponds,” said Wei. Related article: How to achieve successful shrimp crop in Vietnam, May/ June 2023, p18-20-20, https://bitly.ws/3eR7N
Proven to substitute up to 100% of Artemia cysts use
Promotes growth and survival
Artemia Nauplii EPA (mg/g) 6,0 10,7 DHA (mg/g) 0,2 17,6
Copepods
Ready for a positive change? Try now and unlock the incredible benefits of incomparable nutrition.

Only the best from the sea.
Wei touched on the challenges of implementing changes in farming practices, particularly regarding water exchange rates and overcoming ingrained habits. He emphasised the importance of repeated education and reinforcement to create meaningful change among farmers to break old habits.
Feeding shrimp is very complicated. “Shrimp is barely visible to the feeding team and then there is the slow consumption of each pellet,” said Dominique P Bureau, Department of Animal Biosciences, University of Guelph, Canada.
Let’s aquaculture together
www.megasupply.com
orders@megasupply.net


EXCLUSIVE DISTRIBUTOR FOR VIETNAM
www.thuysanOPS.com
/ 0913753035
EXCLUSIVE DISTRIBUTOR FOR INDIA salesorangeenterprise@gmail.com
+91-9962525791
are entered in the system. The software also provides feed requirement estimates for the crop of animals. If the animals are performing better than the benchmark, the model recalculates the feed ration and indicates to the farmer that the animals may need more feed.

Figure 3. Top: a simulation on body weight forecast based on growth potential and industry benchmark. Bottom: Graph estimates feed requirement of the animals contrasted with the
& Chief Scientific Officer, Wittaya Aqua International. He added that estimating inventory becomes challenging because mortality is high and is very difficult to predict.
“Despite the state-of-art in technology, there is a disconnect on what is applied at the farm and what should be applied. Farms often rely on simple techniques for feeding management with various methods to determine the animals’ appetite and distribute feed, including feeding trays, charts, and added to this, personal experience.”
There is evidence that farms have difficulties in predicting mortality rates, managing standing biomass, leading to frequent feed wastage and high economical feed conversion ratios (eFCR). “Poor feeding management negatively impacts productivity and profitability, often resulting in higher-than-expected FCR. With waste feed discharged into the environment, water quality parameters deteriorate, and this can affect the growth and health of the animals,” said Bureau.
eFCR against SR
Bureau illustrated with a graph, of eFCR against survival rate and how the theoretical model estimates show a small impact of mortality on eFCR but based on reported farm data, there was a larger effect. The reason is that the farmers have been over feeding because most probably biomass data are not available.
Smart feed management
There are three elements to smart feed management: long term prediction of how much the animal needs feeds based on expected growth performance; short term variation such as water quality; and stress and correction for biased information,
“A rational, biologically driven approach to feeding is essential; this will minimise wastage while allowing animals to reach their full growth potential.”
To address these challenges, smart feeding management practices are crucial. “Integration of bioenergetics and nutrient-flow models have proven over the years to be effective in predicting feed requirements,” said Bureau. Such models have been developed for shrimp and have recently been integrated into a commercial farm production management software (AquaOp Farm).
In a specific example (Figure 3), Bureau demonstrated how the model starts with predicted growth trajectory based on an industry benchmark calculated by compiling data from numerous farms. The program recalculates as the actual measure of growth of the animals are entered in the system. The software also provides feed requirement estimates for the crop of animals. If the animals are performing better than the benchmark, the model recalculates the feed ration and indicates to the farmer that the animals may need more feed.
Figure 3. Top: a simulation on body weight forecast based on growth potential and industry benchmark. Bottom: Graph estimates feed requirement of the animals contrasted with the amounts distributed by farm personnel. Source: Dominique Bureau, 2023. Smart Feed Management for Sustainable Shrimp Aquaculture. Presented at TARS 2023.

Industry needs a better feeding management system, and we have the opportunity to combine ration, logic, and equipment technology together in developing smart feed management.”
Dominique P Bureau
Additionally, improved biomass estimation models and enhanced employee training are needed to optimise feed management. Significant bias exists in farm estimates of standing biomass, but a combination of farm data inputs and effective models give reliable estimates of standing biomass.
Bureau said, “Industry needs a better feeding management system, and we have the opportunity to combine ration, logic and equipment technology together in developing smart feed management.”
By embracing smart feeding practices and leveraging technology, aquaculture farms can enhance efficiency while ensuring the well-being of their shrimp populations.
In the pursuit of sustainable aquaculture and path towards environmentally responsible shrimp farming, Bjorn Kok, University of Stirling, and Sustainability Consultant at Blonk Sustainability, shed light on the pivotal role of Life Cycle Assessment (LCA) in understanding and reducing the environmental footprint of shrimp production. The demand for sustainable products comes from policy makers, investors, and industry itself.
LCA is a quantitative evaluation of a product’s environmental impact, addressing the growing need to reduce environmental pressure due to growing global population and demand for food. Kok provides an example that reducing the amount of fish meal might only lead to a small reduction in the pressure on the marine environment but a large increase in the amount of land required to produce plant ingredients to substitute that fish meal. “Therefore, all phases of production from feed ingredients used in farming, diesel usage, processing and ultimately usage by the end consumer ought to be taken into consideration,” said Kok.

Bjorn Kok said, “Some greenhouse gases (GHG) are being produced in the ponds from feed wastes. A lower digestible protein means more wastes in the water.”
ultimately usage by the end consumer ought to be taken into consideration, said Kok. He listed the steps in LCA.

is building step by step the factors that can influence biomass predictions. “We develop the science, and the development team translates the science and work with clients and back and forth”.
Farthing explained how the quantification of mortality during siphoning was done. “We also do checks as there are certain facts. FCRs cannot go below a certain point. So, if you see FCRs you can derive limitations to your population. We may get within ±10 estimations. We are working towards consistency and better logic.”
In conclusion, Bador emphasised the need for continuous improvement and adaptation to meet consumer expectations and market demands. “To prepare for the future, we need more data than we have today. It’s better to have as much as possible, have experts analyse this data and we’ll have the farmers making better decisions.”
By analysing the LCA of shrimp production (Figure 4), land use such as deforestation for soybean production in South America or clearing of mangroves for shrimp ponds has adverse impacts. Feed production itself has a small contribution as it is mainly the ingredients that go into the feed. The actual farming has a large contribution mainly due to the energy consumption at the farm such as diesel generators. Some greenhouse gases (GHG) are being produced in the ponds from feed wastes. A lower digestible protein means more waste in the water.
Bjorn Kok said, “Some greenhouse gases (GHG) are being produced in the ponds from feed wastes. A lower digestible protein means more wastes in the water.”
By analysing the LCA of shrimp production (Figure 5) land use such as deforestation for soybean production in South America or clearing of mangroves for shrimp ponds has adverse impacts. Feed production itself has a small contribution as it is mainly the ingredients that go into the feed. The actual farming has a large contribution mainly due to the energy consumption at the farm such as diesel generators. Some greenhouse gases (GHG) are being produced in the ponds from feed wastes. A lower digestible protein means more waste in the water.

Herve Lucien-Brun, and Dominique Bureau.
Kok explained how interventions like digestive enhancers can significantly reduce the carbon footprint of shrimp. Aqualyso® (Adisseo) reduces shrimp carbon footprint by 16%, with improved FCR. However, Kok cautioned that different methods give different results and recommends adopting external verification and transparency on data provided by suppliers or companies.
Kok explained how interventions like digestive enhancers can significantly reduce the carbon footprint of shrimp. Products from Adisseo, Aqualyso® and Sanacore® reduce shrimp carbon footprint by 16-38%, with improved FCR and survivals, respectively. However, Kok cautioned that different methods give different results and recommends adopting external verification and transparency on data provided by suppliers or companies. “We should not just believe in marketing claims.”
Collaborative efforts, facilitated by organisations like IDH (Netherlands based NGO) and Sustell (dsm-firmenich), encourage transparency and collective action in reducing the environmental footprint of aquaculture. These tools help you to reduce the complexity in calculating carbon footprint.
Kok urges stakeholders to embrace LCA as a tool for informed decision-making and sustainability integration. By measuring environmental footprints, identifying hotspots, and incorporating LCA into the decision processes, shrimp farmers can head towards a future of thriving and sustainable aquaculture practices.
Bador emphasised the need for a scientific approach to shrimp farming, highlighting the importance of moving away from intuitive or traditional methods towards evidence-based practices. He stressed that farmers cannot fully comprehend the needs or experiences of shrimp and thus should rely on data-driven decisionmaking.
Farthing highlighted the issue of data reliability and the challenges of data collection in aquaculture. He emphasised the need for intentional and meticulous data collection processes, acknowledging that only a small percentage of collected data may be usable for analysis.
The elephant in the room is how many shrimp are in the ponds. An accurate estimation of shrimp populations is crucial. In their modelling work, Bureau said that it


With concerns on health and food safety, a game changing product enhances microbial control and quality of farmed vannamei and monodon shrimp and freshly caught shrimp
By Daniel Gilaranz

Melanosis, commonly known as blackspot, has plagued the seafood industry and culinary world for ages, casting a shadow over their vibrant appearance postmortem. As a result of oxidation and enzymatic reactions, this darkening phenomenon has led to a search for a solution that does not compromise taste or safety.
Historically, sulphiting agents such as sodium bisulphite and sodium metabisulphite (SMBS) has been relied upon, but their detrimental side effects and allergenic properties have raised serious concerns. As stringent sulphite regulations sweep across Europe, coupled with a global movement towards sustainability and worker well-being, a groundbreaking alternative which has been proven effective, is fast replacing the use of sulphites.
After years of innovative research in various regions worldwide, especially in Southeast Asia and Latin America, PrawnFresh™ Ultimate (Xyrex Ltd, UK) has emerged as a game changer. The product shows unparalleled efficacy in preserving the freshness and quality of wild-caught and farmed shrimp, including the popular species Penaeus vannamei and Penaeus monodon
Black spot and shrimp quality
Black spot, the natural formation of dark pigments mainly in the cephalothorax and joint regions, is a very common problem in crustaceans during post-harvest storage. It is caused by the enzymatic oxidation of phenolic compounds. It occurs due to biochemical reactions; catalysed by polyphenol oxidases (PPO) enzymes and dark pigments called melanin are created. Melanosis causes no direct harm to consumers, but it damages the sensory features
of crustaceans, decreasing their quality, shelf life, and subsequently, their commercial value. Thus, this is more a cosmetic problem rather than a health risk. A close relation between deterioration and storage temperature, immediately after harvesting means that the shrimp must be cooled to the melting ice temperature quickly (Gonçalves & Menezes de Oliveira, 2016).
The seafood industry’s concerns over the appearance and cost effects of shrimp with melanosis are driven by a combination of consumer expectations, adherence to new quality standards in EU and USA, and economic implications which lead to potential price reduction in the market. Maintaining a highquality appearance contributes to premium pricing and competitive advantages in the market.
Worldwide, sulphites are used as inhibitors of melanosis, but they are frequently linked to allergic reactions and asthmatic attacks in humans. The potential risks of using these chemical additives, with symptoms like nausea, abdominal pain, vomiting, and choking have raised awareness among consumers and regulators.
PrawnFresh is a more complete product and avoids the use of sulphites. It is a natural, safe, and effective additive for use in different shrimp species. The innovative formulation of liquid sulphite-free concentrate maintains the organoleptic properties, inhibiting the PPO enzyme responsible for blackspot/melanosis development. Its use is much safer and more effective than sulphite-based treatments. More importantly, there is the issue of workers welfare. The product has a positive impact on the health and safety of employees and protects users from the acid vapours of other products such as SMBS.
It maintains the organoleptic properties of the product, such as freshness, and enhances the original sheen, colour and texture for longer than other treatments.
There is the testimonial from David McRobbie, Skipper of the vessel Karen Ann FR559, UK. “I have been using PrawnFresh for over 3 years. Since the change, our prawns have looked a lot brighter and we have seen a 7% increase in yield. PrawnFresh pays for itself, is user friendly and does not do any damage to our dipping tank. All in all, it is a very good product to use. Our prawn processor, Fraserburgh Seafood has also changed to PrawnFresh.”
A sulphite-free specially designed treatment for the
• Meets all regulatory requirements in the EU, USA, China, Latin America and S.E. Asia. 100% replacement for SMBS.

OPTIMAL ANTIMICROBIAL AGENT FOR REDUCING SPOILAGE BACTERIA IN RSW TANKS OF PELAGIC FISHING VESSELS

A proprietary liquid solution used to control spoilage bacteria. Controls the three main areas of degradation; bacterial decay, enzymatic reactions and chemical oxidization.
• Highly concentrated,1 litre will treat 10 tons of fish

• Dramatically reduces bacterial count in RSW tanks.
• Keeps tanks clean, reducing maintenance costs and downtime.
• Substantially lowers TVN.
• Significantly improves the quality and appearance of fish to maximize shelf life.



Xyrex U500™ is designed specifically to reduce bacterial counts existing in seafood immediately after capture in both holding and processing areas. For use prior to icing.

A food safe general disinfectant for use in seafood processing factories, laboratories, poultry processors, dairy facilities, food production and indoor sports arenas.
A NOVEL DISINFECTING AGENT SPECIFICALLY DESIGNED TO ELIMINATE NUMEROUS BACTERIAL STRAINS
• Extremely effective in reducing spoilage and controlling Listeria (L Monocytogenes) during salmon processing.
• Effective on fungi and yeast strains.
• Dramatically reduces total bacterial counts on multi-species bacteria.
• Safe to use on food surfaces.
• Dilutes from 20:1 up to 100:1.


XYREX are world renowned manufacturers of innovative technologies for the fishing, seafood processing and aquaculture industries.
Fully approved by a number of leading regulatory authorities, our products can significantly increase the value of harvested fish and crustaceans.

For more information contact your nearest distributor or speak to one of our team on:
T:+44 141-567-5646
• E: gerry@xyrex.com www.xyrex.com




The application of PrawnFresh is simple and can be done either manually or mechanically during harvesting of both shrimp species. After harvesting shrimp from the pond, they must be chilled as soon as possible by dipping them in a tank with water and ice. The chilled shrimp can then be placed in either crates or bins for processing and transportation.
It is important to dip the shrimp with the ice/water mixture or slurry ice for the required time followed by correct cold chain procedures to transport the shrimp to the processing plant. Some companies have also used treatment at the plant by using live shrimp transport with oxygenated water. It is crucial to rapidly chill the harvested shrimp immediately after harvest while they are still alive, and maintain cold chain conditions throughout processing to prevent early development of melanosis.
We have conducted several trials following the above post-harvest procedures and then applying PrawnFresh in the treatment group and compared the onset of melanosis in the control group with no application of the additive.
In these trials, a thermometer was used to control the temperatures of the shrimp and the ice/water mixture. The ice slurry with PrawnFresh solution was prepared at below 4°C. A minimum of three replicates, each with a control (no treatment) comparison, was performed. If crates were used, shrimp were immersed in tanks containing a mixture of water and ice. If bins were used, they were partially filled with the ice/water mixture or slurry ice.
The cold chain was maintained throughout the process, from shrimp chill killed until the product was inside the freezer. Samples were evaluated after 48 hours, 15 days, 30 days, 60 days, and 90 days after freezing.
Under these conditions, the sulphite-free additive showed a 100% melanosis inhibition in raw and cooked products under cold storage for more than 90 days. The product forms included head on shell on (HOSO), tailon, and individual quick frozen (IQF). Figure 1 and Figure 2 illustrate the results of treatments in shrimp.
PrawnFresh, in combination with the principal molecules of E-586 and natural compounds in its formula,
effectively inhibits PO (phenoloxidase) activity, a key factor in melanosis development. In contrast to sulphites, E-586 does not provide bleaching activity which retards and inhibits melanin development.
An analysis revealed that when plated, shrimp treated with the sulphite free additive, exhibited exceptionally high quality. The natural compounds and E-586 of the formula had a combined and enhanced effect of bacteriostasis (bacterial inhibition without destruction), which was consistent with the results of earlier in vitro experiments, and the shelf life of shrimp was prolonged by about 6 days when shrimp are chilled indicating a higher level of preservation compared to other methods. The composition of microorganisms observed varied depending on multiple factors, including treatments, handling procedures, and cold chain management.
The findings of these studies suggest that the use of this additive not only minimises environmental impacts, but also provides a safe alternative to the traditional use of sulphites for combating melanosis and extending the shelf life of vannamei and monodon shrimp. Furthermore, by following these protocols, the shrimp industry can produce high-quality shrimp products that meet sustainable labels and safety standards.
Efforts towards sustainability are yielding positive results, as society increasingly demands responsible and transparent industries. Current regulations in Europe highly favour the utilisation of sulphite-free applications; PrawnFresh offers a solution for safe and responsible shrimp processing, meeting these evolving expectations.
Reference
Alex Augusto Gonçalves & Adriene Rosceli Menezes de Oliveira, 2016. Melanosis in crustaceans: A review, LWT - Food Science and Technology, 65: 791-799. doi.org/10.1016/j.lwt.2015.09.011. A.

natural defences
By Stéphane RaliteThis is a nutritional tool with proven efficacy on the infectious and non-infectious arm of the natural defences
Effec%ve disease preven%on strategies in shrimp farming rely on good management prac%ces to preserve a quality environment and reinforce shrimp health and robustness. Nutri%onal strategies can help preserve farmers’ revenues by suppor%ng shrimp immunity. A novel deriva%ve (YANG) specially developed to elicit a balanced immune response confirms its benefits on overall shrimp innate immunity, which translates to higher produc%on performance (feed conversion and mortality). Below we describe the newest trial results.
By Stéphane RaliteBalancing shrimp immune defences
Effective disease prevention strategies in shrimp farming rely on good management practices to preserve a quality environment and reinforce shrimp health and robustness. Nutritional strategies can help preserve farmers’ revenues by supporting shrimp immunity. A novel yeast derivative (YANG) — specially developed to elicit a balanced immune response — confirms its benefits on overall shrimp innate immunity, which translates to higher production performance (feed conversion and mortality). Below we describe the newest trial results.
For shrimp, efficient mechanisms against pathogens consist of several lines of defenc
1. Physical barriers (cu%cle and mucus),
2. The immune system (cellular and humoral),
3. An%oxidant responses (oxida%ve “stress” and detoxifica%on), and
As with all invertebrates, and contrary to that in fish or terrestrial animals, shrimp do not have an adaptive (or “memory”) immune system. Thus, classical vaccination strategies are impossible when it comes to disease prevention. However, there are some pattern recognition receptors that can activate different immune pathways and elicit an immune response.
4. Other defence systems (apopto%c response, cell death and RNA interference).
Balancing shrimp immune defences
For shrimp, efficient mechanisms against pathogens consist of several lines of defence:
1. Physical barriers (cuticle and mucus),
2. The immune system (cellular and humoral),
3. Antioxidant responses (oxidative “stress” and detoxification), and
4. Other defence systems (apoptotic response, cell death and RNA interference).
Long lasting and efficient protection includes both infectious immunity (i.e., the ability to kill the pathogen), and non-infectious (e.g. antioxidant protection, physical barrier) immune response (Figure 1).
As with all invertebrates, and contrary to that in fish or terrestrial animals, shrimp do have an adap%ve (or “memory ”) immune system. Thus, classical vaccina%on strategies impossible when it comes to disease preven%on. However, there are some paVern recogni%on receptors that can ac%vate different immune pathways and elicit an immune response.

The use of functional ingredients should promote both infectious immunity and support non-infectious defence mechanisms and mucosal barrier robustness to ensure overall protection.
YANG (Lallemand Animal Nutrition) is based on the association of complementary yeast strains with a patented synergistic effect on the immune system, which confers a balanced immune modulation power. Shrimp trials prove its benefits on both types of immune response.
Two trials were conducted in Thailand with YANG on juvenile whiteleg shrimp ( Litopenaeus vannamei ) to evaluate the effects of the yeast-based functional ingredient on shrimp immune parameters in the haemolymph compared to a control group.
The investigators observed:
• Increased immune cell counts in the haemolynph (total haemocytes and large granular cells) in both trials;
• Higher phagocytic activity and higher melanisation enzymes and respiratory burst activity (O2-), signs of higher immune activity and pathogen killing processes (Figure 2);
• Significantly higher lysozyme activity, a broad spectrum antimicrobial enzyme;
• Improved gut microvilli density, which is associated with gut health: the digestive functions and gut absorption capacity are preserved, the risk of pathogen translocation is reduced (Figure 3).
Together, these data indicate that, under non challenging conditions, YANG is able to support shrimp immune protection.





Another commercial trial was conducted in Tianjin, China in 2022 also on juvenile L. vannamei. The trial compared a standard commercial feed to the same feed supplemented with increasing levels of the yeast derivative YANG at 0.6, 1.0, 1.4 or 1.8kg/tonne of feed. At day 56, shrimp were challenged with Vibrio parahaemolyticus (0.1mL/shrimp at 2x10⁷ CFU/mL).
This time, the goal was to evaluate the effect of YANG supplementation on noninfectious immunity, such as antioxidant defences, intestinal health, growth performance and survival of L. vannamei These measurements complemented previous research and gauged the impact of the treatments on a Vibrio challenge.
Each week the following parameters were measured:
• Intestinal structure: Intestinal villi height and muscle thickness; goblet cells diagnostic,
• Tissue analysis in both the haemolymph and hepatopancreas were conducted to evaluate various markers of oxidative stress and antioxidant defences,
• Shrimp growth performance: Body weight; average daily gain; feed conversion ratio (FCR) and survival.
These data showed a clear positive dose-response effect of the supplement on shrimp antioxidant defences at most time points. The benefits appear to increase with prolonged duration of use (Figure 4). As a result, decreased levels of oxidative damage and oxidative stress were measured in both the haemolymph and the hepatopancreas.
This shows that YANG supports shrimp antioxidant defences both under normal conditions and following a challenge.
Evaluating measurements of shrimp intestinal structure indicated the supplement also enhanced the robustness of the intestinal barrier, another important defence element against a noninfectious challenge. Indeed, the juveniles fed the yeast supplement showed improved gut barrier development with significantly longer gut villi within 14 days of application. This effect was already observed in previous trials. Moreover, at the higher doses, increased presence of goblet cells was found. These are the mucusproducing cells of the gut lining, which play a key role in the intestinal barrier function.




As a result of improved immune status, the shrimp were better prepared to face the challenge as proven by their survival rate post-challenge (Figure 5). It was significantly improved with the supplement from the lowest dose in a dose-response manner. The supplement improved resilience after facing the pathogen.
In the same trial, growth performance was significantly improved for each dosage (Figure 6). This is in-line with previous trials performed under pathogen challenge conditions (early mortality syndrome or EMS, Enterocytozoon hepatopenaei or EHP, etc.).
This trial illustrates YANG’s contribution to shrimp noninfectious defences including innate oxidative defences and gut barrier function. This leads to improved resilience to a Vibrio challenge, as seen with improved survival and growth performance despite the challenge. The shrimp are better prepared to face the pathogen. In addition, the dose response testing helps inform dose selection according to the local target and level of challenges.
This trial illustrates YANG’s contribu%on to shrimp noninfec%ous defences including innate oxida%ve defences and gut barrier func%on. This leads to improved resilience to a Vibrio challenge, as seen with improved survival and growth performance despite the challenge. The shrimp are beVer prepared to face the pathogen. In addi%on, the dose response tes%ng helps inform dose selec%on according to the local target and level of challenges
This trial illustrates YANG’s contribu%on to shrimp noninfec%ous defences including innate oxida%ve defences and gut barrier func%on. This leads to improved resilience to a Vibrio challenge, as seen with improved survival and growth performance despite the challenge. The shrimp are beVer prepared to face the pathogen. In addi%on, the dose response tes%ng helps inform dose selec%on according to the local target and level of challenges
Conclusion
Conclusion
YANG is a unique associa%on of yeast frac%ons documented to modulate animals’ immune responses The modes of ac%on of YANG on immune response are documented in vitro as validated by a patent. Interes%ngly, laboratory and commercial trials in shrimp indicate that it has a posi%ve influence on several levels of shrimp immune defences.
YANG is a unique associa%on of yeast frac%ons documented to modulate animals’ immune responses The modes of ac%on of YANG on immune response are documented in vitro as validated by a patent. Interes%ngly, laboratory and commercial trials in shrimp indicate that it has a posi%ve influence on several levels of shrimp immune defences.
YANG is a unique association of yeast fractions documented to modulate animals’ immune responses. The modes of action of YANG on immune response are documented in vitro as validated by a patent. Interestingly, laboratory and commercial trials in shrimp indicate that it has a positive influence on several levels of shrimp immune defences.
While vaccina%on strategies and specific immune response are not an op%on in shrimp, having a nutri%onal tool with proven efficacy on the infec%ous and noninfec%ous arm of the natural defences is a good strategy to help preserve health
While vaccina%on strategies and specific immune response are not an op%on in shrimp, having a nutri%onal tool with proven efficacy on the infec%ous and noninfec%ous arm of the natural defences is a good strategy to help preserve health Moreover, the supplement benefits gut integrity and development (villi height), which leads to significant growth and feed conversion improvement.
Moreover, the supplement benefits gut integrity and development (villi height), which leads to significant growth and feed conversion improvement.
-end-
-end-
While vaccination strategies and specific immune response are not an option in shrimp, having a nutritional tool with proven efficacy on the infectious and noninfectious arm of the natural defences is a good strategy to help preserve health. Moreover, the supplement benefits gut integrity and development (villi height), which leads to significant growth and feed conversion improvement.

Stéphane Ralite is Shrimp Product Manager at Lallemand Animal Nutrition.
The microsporidian Enterocytozoon hepatopenaei (EHP) remains a huge health challenge in our shrimp industry and often leads to the infection of opportunistic pathogens causing early mortality syndrome (EMS), white faeces syndrome, etc. However, although EHP does not appear to cause high mortality, it is associated with severe growth retardation and degraded feed conversion ratios (FCRs) in shrimp leading to economic losses for the farmers, who in the worst-case scenarios, need to decide for an early harvest. This disease severely impacted the industry in 2023.
In this article, we describe some new tests conducted in Thailand which consolidate the story of a new prophylactic feed solution developed by MiXscience (France). These studies are a continuation of a trial started 3 years ago when it was proven that this solution inhibits germination of EHP spores at the laboratory scale and reduces the impact of EHP in white shrimp at the field level (Frouel et al, 2021 and Frouel et al, 2023).
least the cell entry is controlled. This is a fundamental point when deciding on recommendations for the application of this new biosecurity tool.
The infective phase is the only phase that can survive without the host since spores are outside of the host’s cells in a dormant and more resistant form Once in the host, the dormant spore will become an infective one through the key phase of the cycle: germination. This phase is notably marked by the expression of an essential tool for the spore to replicate - the polar tube. Thanks to it, the germinated spore will puncture the plasma membrane of the host’s cell, releasing sporoplasms (infectious material) inside the cytoplasm of the cell. The sporoplasms start to replicate in many copies which are released into the environment after killing the cells, and eventually infect other shrimp.
Since EHP has an internal phase during which spores enter the host’s cells, it is important to ensure that the parasite is inhibited from entering the host’s cells or at least the cell entry is controlled This is a fundamental point when deciding on recommendations for the application of this new biosecurity tool
Reducing impact of the EHP load
Previous studies demonstrated that a solution (A-Coverost, MiXscience) based on an innovative blend of oleochemicals associated to a specific active matrix (Figure 2) significantly reduces the capacity of EHP spores to germinate and express the polar tube directly linked to their capability to be infective This effect clearly impacts the final EHP load in hepatopancreas and helps to restore good shrimp performance.
Previous studies demonstrated that a solution (A-Coverost) based on an innovative blend of oleochemicals associated to a specific active matrix (Figure 2) significantly reduces the capacity of EHP spores to germinate and express the polar tube directly linked to their capability to be infective. This effect clearly impacts the final EHP load in hepatopancreas and helps to restore good shrimp performance.
More on the fine mechanisms of action of a new prophylactic feed solution to clarify its impact on EHP
An induction of a specific alteration of EHP spore membrane leads to a disruption in the infection cycle
The life cycle of this microsporidian parasite can be divided into three phases: the infective, the proliferative and the spore-forming phase (Figure 1).
The microsporidian Enterocytozoon hepatopenaei (EHP) remains a huge health challenge in our shrimp industry and often leads to the infection of opportunistic pathogens causing early mortality syndrome (EMS), white faeces syndrome, etc. However, although EHP does not appear to cause high mortality, it is associated with severe growth retardation and degraded feed conversion ratios (FCRs) in shrimp leading to economic losses for the farmers, who in the worstcase scenarios, need to decide for an early harvest. This disease severely impacted the industry in 2023.
The infective phase is the only phase that can survive without the host since spores are outside of the host’s cells in a dormant and more resistant form. Once in the host, the dormant spore will become an infective one through the key phase of the cycle: germination. This phase is notably marked by the expression of an essential tool for the spore to replicate - the polar tube.

The shrimp trials, carried out from 2021 to 2023, notably with EHP cohabitation approaches confirmed the effect of the product under different contexts and breeding conditions: country, Vietnam versus Thailand; shrimp genetics; EHP strains; food, pond conditions, etc (Frouel et al, 2021 and Frouel et al, 2023).
In this article, we describe some new tests conducted in Thailand which consolidate the story of a new prophylactic feed solution developed by MiXscience (France). These studies are a continuation of a trial started 3 years ago when it was proven that this solution inhibits germination of EHP spores at the laboratory scale and reduces the impact of EHP in white shrimp at the field level (Frouel et al, 2021 and Frouel et al, 2023).
Thanks to it, the germinated spore will puncture the plasma membrane of the host’s cell, releasing sporoplasms (infectious material) inside the cytoplasm of the cell. The sporoplasms start to replicate in many copies which are released into the environment after killing the cells, and eventually infect other shrimp.
The shrimp trials, carried out from 2021 to 2023, notably with EHP cohabitation approaches confirmed the effect of the product under different contexts and breeding conditions: country, Vietnam versus Thailand; shrimp genetics; EHP strains; food, pond conditions, etc. (Frouel et al, 2021 and Frouel et al, 2023).
The life cycle of this microsporidian parasite can be divided into three phases: the infective, the proliferative and the spore-forming phase [Figure 1].
Since EHP has an internal phase during which spores enter the host’s cells, it is important to ensure that the parasite is inhibited from entering the host’s cells or at

Figure
A-Coverost, at 4 kg/tonne of feed has the same efficacy when applied directly by pelleting or indirectly by top coating (Figure 3). Based on the cycle of infection of EHP, the preventive approach remains our recommendation to ensure that spores are killed or inactivated during their free phase out of the hepatopancreas cells.
We assume that A-Coverost disturbs the membrane of EHP spores. With the aim of consolidating the positioning of our product and better explaining its mechanisms of action, in 2023, additional tests have been carried out to answer the following questions:
• Is A-Coverost sporicidal or only spore static, meaning what is the direct impact of the product on the viability of EHP spores?
• Does it kill them or just inactivate them?
The latest experimental studies were performed at the National Center for Genetic Engineering and Biotechnology facilities (BIOTEC, Thailand) and consisted of examinations involving scanning electron microscopy (SEM) coupled with epifluorescence
Figure 2. Illustration of the mechanisms of action of the tested product. Figure 2. Illustration of the mechanisms of action of the tested product.microscopy (and in particular with markers of cellular integrity and viability).
These involved the evaluation of the direct effect of A-Coverost tested at 2, 4, 6 and 8g/L on EHP purified spores. Monitoring by SEM allowed us to understand the impact of the product (tested at different dosages) on the morphology of the spores, their ability to germinate and therefore their potential in infecting shrimp. In parallel, a marking with acridine orange and propidium iodide was implemented to measure the impact on spore viability.
Acridine orange (AO) is a red/orange-fluorescent dye used in epifluorescence microscopy and flow cytometry. When AO is used, it helps to detect DNA denaturation or to detect DNA damage (Darzynkiewiczet al, 2004 and Evenson et al, 1980). Propidium iodide (PI) is a red-fluorescent dye. The use of PI is not exclusive only to live cells; it is also commonly used to detect dead cells in a population. PI is used as a DNA stain in flow cytometry or epifluorescence to evaluate cell viability. PI is not membrane-permeable, making it useful to differentiate necrotic, apoptotic, and healthy cells based on membrane integrity (Suzuki et al, 1997).
The EHP spores used were purified according to a standard protocol developed by the center (Aldama-Cano et al., 2018). The active purified spores (1x107 spores) were mixed with A-Coverost at the final concentration of 8g/L. The solutions were incubated for 120 minutes at room temperature (25-26°C), before being subjected to centrifugation at 10,000rpm for 5 min.
The treated spores were washed twice with 1X PBS (phosphate-buffered saline) and 10 µL were placed on round coverslips which were then placed in a 24-well plate and allowed to air dry. The dried coverslips were fixed with 2.5% glutaraldehyde in 0.1M PBS buffer incubated at 4°C overnight. Treated spores on coverslips were washed twice with 0.1M PBS for 10 min each and fixed with 0.1% osmium tetroxide in the dark. Spores were washed twice with 0.1M PBS for 10 min and dehydrated with alcohol in series, drying with liquid CO2, and spray coating with gold. The morphology of EHP spores was examined using a Hitachi SU8010 scanning electron microscope.
AO and PI were diluted in PBS. The two products were mixed at a ratio of 1:1 and 3 μ L of AO/PI mixture were mixed with approximately 20 μ L of spore sample. The solution was placed on a slide then analysed under an epifluorescence microscope.
A-Coverost, at 4 kg/tonne of feed has the same efficacy when applied directly by pelleting or indirectly by top coating [Figure 3] Based on the cycle of infection of EHP, the preventive approach remains our recommendation to ensure that spores are killed or inactivated during their free phase out of the hepatopancreas cells.

We assume that A-Coverost disturbs the membrane of EHP spores With the aim of consolidating the positioning of our product and better explaining its mechanisms of action, in 2023, additional tests have been carried out to answer the following questions:
• Is A-Coverost sporicidal or only spore static meaning what is the direct impact of the product on the viability of EHP spores?
• Does it kill them or just inactivate them?


The results indicated the following with A-Coverost:
• The product interacted with the membrane of EHP spores, causing disruption; abnormal morphology of the spores was observed, and they were no longer able to germinate (which confirmed our previous results) and tended to clump together (Figure 3).
• The product induced a loss of sealing of the spores, which involved the marking of the DNA with PI and therefore a reduction in the viability of the spores.
We observed a very marked dose effect with an average mortality of the spores of 73% when they were exposed to a dose of A-Coverost of 4g/L and a mortality of 95 and 97% when the spores were respectively exposed with doses of 6 and 8g/L (Figure 4).

Conclusion
This new study, conducted in Thailand, completes, and reinforces the previous work. These latest results helped us to better understand the fine mechanisms of this preventive solution. It clearly indicated that the product induces a specific alteration of the membrane of EHP spores leading to an overall disturbance of the EHP biology. That stops its infection cycle.
We understand that a direct interaction between the product and the spore (extracellular phase) is a prerequisite to initiate the inhibition process and to kill the spores. This is why prevention remains the key recommendation and must be associated with strict biosecurity and disease surveillance for an efficient eradication of EHP in shrimp farming systems.

References are available on request


Dr Stephane Frouel is an aquaculture specialist at Mixscience and is responsible for aquaculture project management including feed additives assays and worldwide trials.
Email: stephane.frouel@mixscience.eu

Jérémie Potier is responsible for the business development in Asia of the current solution against EHP disease.
Email: jeremie.potier@groupeavril.com
Maxime Hugonin is an aquaculture specialist and is responsible for the product development of the current solution against EHP disease. He is now Director of Mixscience Asia.
Email: maxime.hugonin@mixscience.eu


Two side by side
Figures
At Aqua India 2024, the session on shrimp diseases and mitigation strategies reviewed some research updates, disease mitigation and diagnostic tools.
Accepting the disease situation in India, the panel, led by Dr D. Ramraj, Director at Padmanabha Labs, discussed how recent research developments could be applied to the industry. Aqua India 2024, the biennial event of the Society of Aquaculture Professionals (SAP), was held in Chennai from February 15-17.
Earlier this year, SAP conducted its annual Shrimp Crop Review 2023 where in a presentation, Kumaresan A, Director at Sheng Long Biotech India, showed data on the prevalence of diseases in coastal and inland shrimp farms. Inland farms are those in Rajasthan, Punjab, Haryana. Together these states contributed to 10,200 tonnes of vannamei shrimp in 2023. Kumaresan noted that in inland farms, outbreaks of white spot syndrome virus (WSSV) was not reported. Neither were there reports on Enterocytozoon hepatopenaei (EHP) or retarded growth. White faeces syndrome (WFS) as well as running mortality syndrome (RMS) was a problem.



To better understand the evolution of viruses in shrimp, APL uses WSSV as a proof-of-concept study. Dr Hung N. Mai, Research Scientist at the Aquaculture Pathology Laboratory (APL) University of Arizona, USA, explained the work with the genome reconstruction of WSSV from archived histological tissue. APL has a collection of >110,000 histology tissue blocks dating back to the mid1970s. The aim is to develop a technology platform to create oral therapeutics to control shrimp diseases. The research on acute hepatopancreatic necrosis disease (AHPND) with In silico analysis of PirA/PirB structure and receptors aims to understand molecular pathogenesis in AHPND to develop disease-resistant lines such as an AHPND tolerant Penaeus vannamei line.
Hung concluded that identifying the etiology of diseases involving more than one pathogen is difficult, but critical to developing management strategies to mitigate those diseases.

The question frequently asked is whether evolved strains of WSSV are more virulent and cause increased mortalities. Contrarily, Hung said Chinese researchers showed that an earlier strain, CN01, showed more virulence than the latter strain CN03, which had low virulence. “In nature, when the virus evolves, it needs to be with the host and stay alive. Therefore, it is not to their advantage to kill the host.”
Updated research information on WSSV transmission pathways is critical in managing farm operations. Professor Uma Arumugam, Head, Department of Health Management, Tamil Nadu Dr J. Jayalalithaa (TNJ) Fisheries University, updated that with new diagnostic essays, researchers continue to identify targets; however, the exact transmission pathway is unclear, partly because there are too many ways this virus can be transmitted.







Disease surveys have pointed out that transmission of WSSV through specific pathogen-free (SPF) post larvae seems unlikely. The horizontal transmission of diseases on farms is of greater magnitude. There is more attention to biosecurity to manage diseases, but it is easy to implement biosecurity on large farms. When farms are small and share resources, a farm that applies good biosecurity is at the mercy of poor biosecurity on neighbouring farms. Hung suggested biosecurity at a community level. There are often higher risks of WSSV outbreaks during the cooler seasons. The panel discussed mitigation steps, such as increasing the health of shrimp with probiotics and functional additives.
Dr Lukas Neumann, Researcher on Aquatic Animal Health, Skretting, updated on an in-feed WSSV RNAi solution developed by ViAqua. The 2-week trial conducted in Belgium had shrimp injected or fed the double-strand RNAi solution and then challenged with the virus.
The results showed that injecting dsRNAi improved survival and that commercially produced dsRNA gave the same results as the that produced by ViAqua. With the infeed trial, there was a successful proof of concept. Although there was no noticeable dose response, the oral delivery of dsRNAi gave an RPS of up to 64%. Next will be field trials.
Dr D Ramesh Kumar, CEO, Salem Microbes, showed data on the microbial load in the hatchery environment, which indicated 2.2 x106 CFU/mL in artemia-holding tanks compared to raw seawater containing 1.70x104 CFU/mL and outdoor algae tanks with 1.0 x103 CFU/mL. However, he cautioned about vibrio buildup in algae culture as hatcheries use many types of algae.
“In recent incidents of vibrio related mortality, we are observing these Vibrio species; Vibrio alginolyticus, Vibrio vulnificus, in addition to Vibrio parahaemolyticus. The severity of infection is equally intense in young shrimp at below DOC 30 as well as in shrimp, towards harvest size of 20-30g. This reiterates the caution for farmers to maintain biosecurity as well as maintain low CFU of vibrios in the
pond water through using probiotics or bacteriophages active against Vibrio species,” said Ramesh.
There is no specific clinical sign. Target organs include the hepatopancreas and midgut, affecting digestion and absorption functions, said Uma. On the screening of post larvae, the panel concurred on the difficulties with accurate PCR detection of EHP. The detection limit is very high, with false negatives at the early stages of detection are not uncommon.
Uma noted that for the past 10-15 years, there has been a reliance on PCR testing, based on an assay which is not specific to EHP. Diagnostic sensitivity has increased with the target on polar tube protein. A team in China and Korea developed a sensitive and specific nested PCR method targeting the EHP ß-tubulin gene. Diagnostic sensitivity has increased with the target on polar tube protein.
Skretting has now identified an ideal product with functions to inhibit EHP spore infectivity and proliferation after in vitro screening tests of 30+ ingredients. Additionally, the product solidifies digestive functionalities.
Uma discussed the work on using albendazole, a broadspectrum anthelmintic and antiprotozoal agent against EHP in vannamei shrimp. The team at TNJU showed that albendazole is an inhibitor of the β-tubulin polymerization in microsporidians. Efficacy was tested in reducing EHP infection in the shrimp at various dosages of albendazole. They found that a 98% reduction in EHP DNA copies was observed in the shrimp treated with 75 mg/L per day for 24 days.
However, work is required on the interventions in broodstock. Although albendazole is a potential drug to control EHP infection in shrimp, which might help to combat the production losses caused by EHP, Uma commented that they need to assess the safety issue for shrimp and the environment and, before any commercial use, get the approval of regulatory authorities.
A pioneer in India’s shrimp aquaculture, Ramraj Dhamodaraswamy expects the industry to remain resilient despite the existential threat of diseases

Ramraj Dhamodaraswamy, a seasoned professional in Indian aquaculture, has dedicated over three decades to navigating the complexities of shrimp farming in India. With a post-graduate degree in Mariculture from the Indian Council of Agriculture Research (ICAR), Ramraj embarked on his journey in 1989 as a biologist in a shrimp farm. Today, he serves in various capacities within industry associations and leads his own ventures in shrimp hatcheries and molecular diagnostic services. His current business includes ownership of a 400 million post larvae (PL) hatchery from SPF Penaeus monodon, a licensed tilapia hatchery and Padmanabha Labs, which provides molecular diagnostic services for the shrimp farming and veterinary sectors.
Ramraj has served as the President of the Society of Aquaculture Professionals (SAP) and the All India Shrimp Hatcheries Association (AISHA). He was an early Aquaculture Certification Council (ACC) Auditor for Best Aquaculture Practices (BAP), served on the governing body of the National Fisheries Development Board (NFDB) and National Knowledge Commission of the Government of India, and was a member of the governing council of the National Centre for Sustainable Aquaculture (NACSA).
Ramraj sheds light on the daunting challenge of disease management in Indian shrimp farming. Annual losses are estimated at over USD1 billion from infectious diseases such as white spot disease caused by white spot syndrome virus (WSSV), vibrio related diseases in hatcheries and farms, microsporidiosis caused by Enterocytozoon hepatopenaei (EHP) and by pathogens of unknown etiology.
“Diseases continue to cast a shadow over the industry’s potential. Imagine, this annual loss is about 20% of the current value of the farmed shrimp exports. We need to see challenges with disease in the Indian context, i.e. the structure of our industry. Small land holdings and shared resources compound biosecurity challenges, while ‘suboptimal husbandry practices’ also contribute to the problem.
Land holdings are small, with 85% of the farms in areas of less than 5ha. Furthermore, 90% of Indian shrimp farms are located away from the coast, drawing and discharging water from brackish water creeks. These creeks have limited carrying capacities as compared to open coastal waters.”
Ramraj also explained that the land parcels used for farming shrimp are continuous and connected, which means that multiple farms share resources such that intake and discharge pose a big challenge in implementing a failproof biosecurity system for effective disease control.
“Poor husbandry practices in pond preparation, PL selection and stocking, water and sediment quality management during the crop by a few farms can exacerbate the disease situation over a large area.”
According to Ramraj, in 2023, India produced more than 800,000 tonnes of shrimp which used about 1.2 million tonnes of feed. Some 80 billion PL were stocked. “If one were to consider the average size at harvest as 60/kg, India would have had a success rate of 60%. Though Indian shrimp farms are quite efficient in feed management, a higher feed conversion ratio (FCR) is attributed to losses due to diseases.”
“Recall that in the past, higher profit margins made up for losses from crop failures, but today, with declining shrimp prices and rising input costs, farmers are under pressure to address disease challenges to sustain farming.”
The Indian shrimp farming industry faces unprecedented challenges, compounded by global market dynamics.
“Shrimp production and supply in the global market are at historic highs and prices are at historic lows. I expect that until new markets are found to absorb the increasing supply, shrimp prices are bound to remain low and this becomes a huge challenge for India,” says Ramraj.
“Recall that in the past, higher profit margins made up for losses from crop failures over 2-3 crops, but today, with declining shrimp prices and rising input costs, farmers are under pressure to address disease challenges to improve production efficiency and sustain farming. Our shrimp farmer does not have the liberty to take risks anymore.”
India had an early start with the infrastructure for shrimp disease diagnostics. With the onset of the WSSV epidemic in the mid-1990s, CP Aquaculture pioneered and MPEDA encouraged, an early adoption of PCR screening for pathogens. A PCR laboratory is a mandated requirement in hatcheries for an operational licence from the Coastal Aquaculture Authority (CAA). As a result, over 500 hatcheries in India have an in-house PCR diagnostic laboratory. Several private PCR laboratories were set up in shrimp farming areas. Today, these laboratories have upgraded to Real time PCR (qPCR), serving farmers and hatcheries. A shrimp farmer can access a Gold Standard qPCR test service in an hour away from a farm or hatchery and get results in 4-5 hours.
“Over the years, a shrimp farmer has learnt to put efforts in PL selection from hatcheries. A farmer exercises great care in screening PL by PCR for multiple pathogens prior to purchase from hatcheries.”
It is interesting to note that during the Covid 19 pandemic, there was an urgent demand for qPCR tests for sick patients. The shrimp industry loaned qPCR machines to government hospitals for emergency use.
“Diagnostics incur costs, a qPCR test in a private laboratory costs less than USD10 for a single pathogen. It costs less for multiple pathogens testing. Investing in diagnostics translates into long-term gains by safeguarding against catastrophic disease outbreaks. “With experience over the years, a shrimp farmer sees a value proposition in PCR tests, This is attested by the continuing confidence in PCR testing of PL by farmers,” said Ramraj.
“Similar to shrimp farms in some parts of Asia, our farmers have an inherent challenge with regard to implementing biosecurity in farms. We know that farmers have to adhere to the basics in best management practices (BMPs) in shrimp farming, such as proper pond soil conditioning, water filtration and treatment to eliminate vectors of shrimp diseases, stock control, and of course stocking healthy PL among others.
“Farmers should know that there is no magic bullet that can be a substitute for basic farm management procedures” emphasises Ramraj.
“Innovations in disease management such as infeed therapeutics and disease tolerant genetics can revolutionise shrimp farming. By emphasising basic BMPs and addressing the shortfalls in husbandry practices in shrimp farms, production efficiencies can be improved significantly. Feed companies will have an increased responsibility in the dissemination of the right technology to the farmers and control of diseases.”
Historically, government interventions have shaped the trajectory of Indian shrimp farming such as setting up commercial scale model shrimp hatcheries in the 1980s or introducing the exotic shrimp Penaeus vannamei in 2009. A series of interventions by the government, such as imports of SPF parent stock from select proven broodstock genetics companies, a centralised quarantine facility, transparency and dissemination of updated information on broodstock imports by hatcheries, along with stringent PL selection process by farmers have contributed to the control of vertical transmission of diseases through PL to farms.
A recent survey and analysis by SAP has shown that transmission of diseases such as WSSV through PLs from SPF broodstock is rather remote and that the horizontal transmission of diseases in farms is quite substantial and needs to be addressed.
While government agencies can facilitate the much needed and exclusive disease surveillance and epidemiological study, industry players must actively participate in implementing biosecurity measures and adopting BMPs to complement governmental efforts. A synergistic approach between the government and industry would be helpful in tackling the challenges posed by diseases.
Despite significant challenges, Ramraj remains optimistic on industry’s future. However, he highlights that the double whammy of low farm gate prices and crop failures due to diseases continue to be an existential threat to India’s shrimp farming industry.
With improved disease-tolerant genetics and therapeutics on the horizon, the industry will survive and remain sustainable in the years to come. However, success depends on a strong focus on proactive disease mitigation measures and a collective commitment to sustainable practices. The journey of Indian shrimp farming reflects a tale of resilience amidst adversity.
“However, if the past is an indicator, being small, Indian shrimp farmers are more resilient during a crisis, as evident during 2000-2009 when industry faced a similar crisis. After all, it’s a livelihood for over 3 million rural population”.
In addition to providing optimum nutrition at minimum cost, the quality of shrimp feeds also affects feed efficiency, water quality, environmental impacts, disease mitigation and sustainable production methods. In intensive shrimp culture, the focus is on precision aquaculture but feeds are also a delivery platform for health interventions with the inclusion of functional additives. Formulators seek optimal use of feed ingredients.
The above needs aligned well with the theme at TARS 2023-Shrimp Aquaculture: Regeneration. Dr Romi Novriadi , Lecturer at the Jakarta Technical University of Fisheries, Ministry of Marine Affairs and Fisheries Indonesia, led the panel discussion to find ways to address feed related issues faced by farmers.

USE THIS
Feed forward: Feed, Enzymes and Beyond
In addition to providing optimum nutrition at minimum cost, the quality of shrimp feeds also affects feed efficiency, water quality, environmental impacts, disease mitigation and sustainable production methods. In intensive shrimp culture, the focus is on precision aquaculture but feeds are also a delivery platform for health interventions with the inclusion of functional additives. Formulators seek for optimal use of feed ingredients.
The above needs aligned well with the theme at TARS 2023-Shrimp Aquaculture: Regeneration. The panel, namely consisting of nutritionists, including session chair Dr Romi Novriadi, Lecturer at the Jakarta Technical University of Fisheries, Ministry of Marine Affairs and Fisheries Indonesia, sought ways to address feed related issues faced by farmers.
Dr Ooi Ei Lin, Regional Manager Aquaculture APAC, Adisseo, Singapore, began her presentation with results of a small survey of five Indonesian farms where multiple infections were occurring during the early part of culture. “As the crops progressed from day of culture (DOC) 60 onwards, the incidences increased and became more diverse. Multiple infections are now a norm,” said Ei Lin.
Harnessing shrimp health with functional nutrition
CeFi ® pro Autolyzed brewers’ yeast
Dr Ooi Ei Lin, Regional Manager Aquaculture APAC, Adisseo, Singapore began her presentation with results of a small survey of five Indonesian farms where multiple infections were occurring during the early part of culture “As the crops progressed from day of culture (DOC) 60 onwards, the incidences increased and became more diverse. Multiple infections are now a norm,” said Ooi.
The successful use of functional additives in 20 ponds over 4 cycles in farms in Lampung, Indonesia (Figure 1) showed that the use of functional additives resulted in higher survival rates and biomass, and improved FCR compared to the control Two strategies were used with a functional health additive: corrective alone and preventive and corrective combined
The successful use of functional additives in 20 ponds over 4 cycles in a farm in Lampung, Indonesia (Figure 1) showed that the use of functional additives resulted in higher survival rates and biomass, and improved FCR compared to the control. Two strategies were used with a functional health additive: corrective alone and preventive and corrective combined.

As infections are increasing and becoming more diverse, industry needs to learn how pathogens modulate metabolism. Ooi noted that white spot infection induces the Warburg effect, lipolysis to release fatty acids which in turn impact shrimp growth
As infections are increasing and becoming more diverse, industry needs to learn how pathogens modulate metabolism. Ooi noted that white spot infection induces the Warburg effect, lipolysis to release fatty acids which in turn impact shrimp growth.
Functional nutrition can help in managing health and nutritional diseases in shrimp farming. “However, with so many targets requiring attention, how should industry
| Rich in nutrients and active ingredients
| High bioavailability of the same
| Stimulates the metabolism
| Promotes feed intake and performance
Visit our website: leibergmbh.de
Leiber GmbH | Franz-Leiber-Str. 1 | 49565 Bramsche
Germany | info@leibergmbh.de
handle pathogens? What should the focus be, nutrition or health? There is no complete answer, and this depends on the planned objective.”

Ooi Ei Lin, said “However, with so many targets requiring attention, how should industry handle pathogens? What should the focus be, nutrition or health?”
Ooi suggested that an understanding of the modes of action of functional additives might help make decisions on tackling this question.
Immune modulation and anti-inflammatory action
In a trial, shrimp were fed control and treatment diets over a 60-day grow-out period. Parameters assessed included growth performance cumulative mortality, histological effects, gene expression and serum biomarkers. Findings showed that gene expression affected two antimicrobial peptides (penaidin and crustin) and was indicative of immunity response. “This is a way to screen additives,” said Ei Lin.
“We went further to challenge shrimp with bacterium such as Vibrio parahaemolyticus (Vp AHPND) and virus. We looked at biomarkers to understand what the additive could and could not do. Biomarkers for immune health showed at the grow out phase, immunity was primed allowing the shrimp to resist the infection. When challenged with Vp AHPND, non-specific immune capacity was more upregulated than in the control, suggesting better cellular immunity against infection.”
Nutrient uptake
Transcriptomics analysis was used to better understand digestive and metabolic enhancers. By analysing KEGG pathways, it was shown that lysophospholipids induced 74% more unique pathways as compared to lecithin (used as the control). A deeper dive showed how lysophospholipids affected lipid absorption, active transport of nutrients and release of nutrients into circulation for use by shrimp. It also initiated phagocytosis, which is important to elucidate immune responses.
Other modes of actions assessed included gut integrity and microbiome as well as quorum sensing. Information on villi height via histology pointed out how to use the additive to recover gut health. Assessment on gut microbiome using principal component analysis (PCA) showed the up and down regulation of bacteria with and without functional additives (Figure 2). Quorum sensing is the communication mechanism for bacteria and there is a way to test effects of different functional ingredients in inhibiting bacterial activity.
“Functional nutrition can play a significant role in disease management in shrimp farming but science-based approaches are necessary for understanding and validating
the modes of action of functional additives. Good farm management practices, in addition to functional nutrition,

Figure 2. PCA analysis on gut microbiome showing shifts in shrimp and the effects of a functional additive. Source: Ooi with functional nutrition. Presented at TARS 2023.
a functional additive.
“Functional nutrition can play a significant role in disease science-based approaches are necessary for understanding functional additives. Good farm management practices, in important for preventing and managing health and nutritional
Achmad Wahyudi, Technical Director at Grobest Indonesia
Achmad Wahyudi, Technical Director at Grobest Indonesia believes that field information can guide the shrimp industry forward. He began by shedding light on the challenges faced by shrimp farmers - rising input costs, volatile farmgate prices, disease outbreaks, and unpredictable weather patterns. Additionally, sustainability has become paramount, urging the industry to seek ways to produce shrimp more efficiently while minimising environmental impacts but this comes at a cost too.
the shrimp industry forward. He began by shedding light on rising input costs, volatile farmgate prices, disease outbreaks, Additionally, sustainability has become paramount, urging shrimp more efficiently while minimising environmental impacts
A primary concern highlighted is the need for highquality feed to achieve optimal growth while keeping costs manageable. Elements of high feed qualitynutritional properties, feed uniformity, water stability, and palatability, play a crucial role in ensuring that shrimp receive the necessary nutrients for growth and health. Next is feed management along the production cycle. What kind of feed will depend on the genetic lines (fast growth, balance and resistant lines), stocking density and growth rate.
A primary concern highlighted is the need for high-quality keeping costs manageable. Elements of high feed qualitywater stability, and palatability, play a crucial role in ensuring nutrients for growth and health. Next is feed management feed will depend on the genetic lines (fast growth, balance growth rate.

Achmad Wahyudi said,
“Lower-protein yet high-nutrition-value feeds could deliver positive results, including improved FCR and reduced waste generation.”
Based on genetic lines and stocking density, feeding protocols are developed to set metrics such as harvest performance, survival rate, growth rate and feed conversion ratio (FCR). Wahyudi stressed, “Selecting the right type of feed, combined with appropriate protein levels and
Figure 3. Average crop profitability (IDR per kg of shrimp harvested) (IDR per kg of shrimp), for GBID ponds stocked with post larvae and with 3 feeding protein levels. Source: Achmad Wahyudi, Protocol for Increased Profitability and Reduced Environmental



Figure 3. Average crop profitability (IDR per kg of shrimp harvested) in relation to investment in feed (IDR per kg of shrimp), for GBID ponds stocked with post larvae (PLs) from 3 different genetic lines and with 3 feeding protein levels. Source: Achmad Wahyudi, 2023. Optimised Feed and Feeding Protocol for Increased Profitability and Reduced Environmental Impact. Presented at TARS 2023.
Figure 3 Average crop profitability (IDR per kg of shrimp harvested) in relation to investment in feed (IDR per kg of shrimp), for GBID ponds stocked with post larvae (PLs) from 3 different genetic lines and with 3 feeding protein levels. Source: Achmad Wahyudi, 2023. Optimised Feed and Feeding Protocol for Increased Profitability and Reduced Environmental Impact. Presented at TARS 2023.
Figure 3 Average crop profitability (IDR per kg of shrimp harvested) in relation to investment in feed (IDR per kg of shrimp), for GBID ponds stocked with post larvae (PLs) from 3 different genetic lines and with 3 feeding protein levels. Source: Achmad Wahyudi, 2023. Optimised Feed and Feeding Protocol for Increased Profitability and Reduced Environmental Impact. Presented at TARS 2023.
Figure 3 Average crop profitability (IDR per kg of shrimp harvested) in relation to investment in feed (IDR per kg of shrimp), for GBID ponds stocked with post larvae (PLs) from 3 different genetic lines and with 3 feeding protein levels. Source: Achmad Wahyudi, 2023. Optimised Feed and Feeding Protocol for Increased Profitability and Reduced Environmental Impact. Presented at TARS 2023.
feeding rates, is essential to achieve the desired return on investment (ROI). The options will be using either functional feeds or conventional feeds.”
Pic
Pic
Pic
By analysing the cost-benefit of each component of the feeding protocol and collaborating with farmers to improve performance, the industry can translate these improvements into enhanced ROI. In Vietnam, Wahyudi showed how farmers improved performance using the Grofarm model leading to better ROI. In Indonesia, they improved ROI to 31% using a regular feed (34% CP) and then to 65% with a functional feed (36% CP) in ponds stocked with 100-146 PL/m 2 . There were also improvements in ROI when the feeding protocol was applied to different stocking densities. “The other variable tested was feeding with feeds containing different crude protein levels (% CP) with stocking density (100-149 PL/ m² or 150-400 PL/m²).”
Adaptability in feeding protocols
Wahyudi also discussed the changes in profitability using post larvae: from fast growth genetics with high protein

feeds (40%); from balance genetic lines fed medium protein feeds (36%) and from resistant line genetics fed low protein (34-28%) feeds (Figure 3). This amplifies the need for adaptability in feeding protocols to account for specific farm conditions, stocking densities, disease challenges, and technical expertise. “Since we realise that feeding protocol is very important, synchronising the genetic line of broodstock and stocking density with types of feed as well as disease prevalence is an urgent need to be realised.”
The combination of functional and sustainable feeds, together with appropriate feeding protocols, showed promising outcomes such as optimised nutrition, enhanced shrimp health, and improved growth and survival rates.
Trials demonstrated that lower-protein yet high-nutritionvalue feeds could deliver positive results, including improved FCR and reduced waste generation. On the mode of action of high-protein diets in minimising environmental impact, Wahyudi emphasised that feeding protocol plays an important role.
RESTRICT inappropriate use of antibiotics and chemicals
REDUCE losses from subclinical disease and outbreaks
INCREASE economical and ecological sustainability
BOOST feed perfomance and farm productivity

Highlighting the importance of water quality management, waste reduction, and nutrient digestibility in sustainable shrimp farming practices, Wahudi concluded, “By adopting sustainable feed practices and implementing appropriate feeding protocols, the industry can head towards a more environmentally friendly and economically viable approach to shrimp farming.”
This relates to contamination with mycotoxins in feed ingredients and finished aquafeeds. Nguyen Ngoc Diem, dsm-firmenich, Aqua Technical Expert, APAC said that the occurrences of several mycotoxins are increasing in shrimp feed. The risks of feeding them to shrimp can result in reduced growth, impaired immune functions, and increased susceptibility to bacterial and viral infections, with significant economic losses for farmers.
“Difficulties in obtaining raw materials have sometimes resulted in their acceptance even though they do not meet or fall below specifications. Issues of climate change, storage, and logistical challenges have led to increased occurrences of mycotoxins in plant raw materials used to produce aquafeeds,” said Diem, adding that fungus is easy to spread and difficult to stop. Some 96% of feed samples showed prevalence of co-contamination.
Aflatoxins, known for their hepatotoxic and carcinogenic properties, were found in 74% of samples, while ochratoxin A, known for nephrotoxicity and teratogenicity, contaminated 54% of samples. Fumonisins, zearalenone, and trichothecenes also exhibited various toxic effects on different organ systems (Figure 4)
The impact of mycotoxins on seafood quality is concerning. Shrimp are highly sensitive to mycotoxins, with negative effects observed even at low contamination levels. “Entirety of the gut can be broken down due to mycotoxin. It’s also lesser known that mycotoxins can affect shrimp flesh quality,” Diem said. She also highlighted studies that demonstrated protein degradation due to mycotoxins, and muscle fibre density reduction due to lipid oxidation (Figure 5)

PIC
Nguyen Ngoc Diem said, “The aquaculture industry can make the invisible mycotoxins visible to reduce the risks posed by fungal pathogens and ensure the safety and integrity of seafood products.”
Mycotoxin risk management
Diem emphasised the importance of good mycotoxin risk management practices, including controlling feed raw material quality, investing in insurance for feed quality assurance, and paying attention to seafood quality. Additionally, there is a need for regulations governing mycotoxin levels in both feed and seafood to safeguard human and animal health. “In livestock there are only a few species being farmed, but in aquaculture we have so many species, which is grouped under fish. There are not enough guidelines that take that into account,” explai ned Diem.
Diem concluded, “By implementing quality control measures, the aquaculture industry can make the invisible mycotoxins visible to reduce the risks posed by fungal pathogens and ensure the safety and integrity of seafood products.
Diem emphasised the importance of good mycotoxin risk management practices, including controlling feed raw material quality, investing in insurance for feed quality assurance, and paying attention to seafood quality. Additionally, there is a need for regulations governing mycotoxin levels in both feed and seafood to safeguard human and animal health. “In livestock there are only a few species being farmed, but in aquaculture we have so many species, which is grouped under fish. There are not enough guidelines that take that into account,” explained Diem.
Understanding mycotoxin contamination
Diem concluded, “By implementing quality control measures, the aquaculture industry can make the invisible mycotoxins visible to reduce the risks posed by fungal pathogens and ensure the safety and integrity of seafood products. “
Serge Corneille, Vietnam asked how can industry gauged damage to shrimp and health. Diem said that sshrimp are more sensitive to fumonisins than other animals or fish. Diem responded, “To see physical effects of a particular mycotoxin, researchers apply mycotoxin at levels beyond that usually recorded at the feed mill. With a fragmented nature of Asian aquaculture, controlling levels at the farm is not easy. In contrast, pangasius feed is consumed quickly within 3 days to a week but I have observed poor storage of shrimp feeds resulting in higher contamination levels than recorded at the feed mill.” Most research is based on single contaminations. Also damaging is the synergistic effects of co-contamination as well as from new emerging mycotoxins.
Balancing feed quality and farming practices
Wahyudi emphasised the importance of balancing feed quality with farming practices to optimise shrimp growth and minimise environmental impacts Ooi noted that leaching aspects should not be

Serge Corneille, Vietnam asked how can industry gauged damage to shrimp and health. Diem said that shrimp are more sensitive to fumonisins than other animals or fish. Diem responded, “To see physical effects of a particular mycotoxin, researchers apply mycotoxin at levels beyond that usually recorded at the feed mill. With a fragmented nature of Asian aquaculture, controlling levels at the farm is not easy. In contrast, pangasius feed is consumed quickly within 3 days to a week but I have observed poor storage of shrimp feeds resulting in higher contamination levels than recorded at the feed mill.” Most research is based on single contaminations. Also damaging is the synergistic effects of co-contamination as well as from new emerging mycotoxins.
Wahyudi emphasised the importance of balancing feed quality with farming practices to optimise shrimp growth and minimise environmental impacts. Ooi noted that leaching aspects should not be ignored especially when additives are top dressed onto feeds. “Leaching is inevitable even for those additives added in the feed plant. Therefore, the feeding strategy is important. Autofeeders disburse feeds frequently for fast feed intake and minimise leaching.”
“Difficulties in obtaining raw materials have sometimes resulted in their acceptance even though they do not meet or fall below specifications. Issues of climate change, storage, and logistical
The potential of functional feed and additives to enhance shrimp health and performance is clear. A collaboration among farmers, feed millers, and suppliers to ensure proper application and maximise benefits is important. Romi asked the panel for comments.
Diem: The fact that many farmers top dress feeds with functional additives indicate that these additives work to improve growth performance and the health of the animal. I see the need for a bottom-up approach for farmers to discuss with feed millers on application methods. Whether at the farm or feed mill, only a small quantity is added, how can we ensure homogeneity in the pellet at the farm level?
Ei Lin: Functional additives have been effective in the salmon industry and we can learn from this industry. There is a lot of research showing effects and next is building trust among farmers and feed millers. We know that there will be additional costs but it’s important to assess this cost over the whole production cycle. Having

Nguyen Ngoc Diem said, “The aquaculture industry can make the invisible mycotoxins visible to reduce the risks posed by fungal pathogens and ensure the safety and integrity of seafood products.”
a solution may make the difference between a successful or failed crop.
Wahyudi: It has been proven scientifically that there was improvement to the immune response of the animal after they were fed with functional feeds.

Dr Romi Novriadi, Jakarta Technical University of Fisheries, Ministry of Marine Affairs and Fisheries Indonesia, left, with the speakers; from second left; Achmad Wahyudi, Grobest, Indonesia; Chi Man, Hong Kong; Dr Ooi Ei Lin, APAC, Adisseo and Nguyen Ngoc Diem, Vietnam.


During this one-day conference, held in Bangkok, Thailand on November 21, there were five presentations revolving around the theme “Power of Nutrition”. These covered industry developments, from shifting priorities in ingredient assessments, quality shrimp feed production and back to basics on carbohydrates and anti-nutritional factors. Gut health with postbiotics was introduced following the acquisition of Adare Biome in July 2023. We published the first part of this report, covering two presentations in issue January/February, p18-41 (https://bitly.ws/3e72r).
Dr Brett Glencross, Technical Director IFFO and Honorary Professor University of Stirling, Scotland, presented “The Evolution of Ingredient Assessment: Shifting Priorities in the 21st Century”. He discussed the use of a precision nutrition approach in modern diets based on nutrients, not ingredients, and a 4-step approach in methodology for ingredient assessment. There is an increasing trend in ingredient diversity but for the future, it is important to have quantitative metrics to measure sustainability.
Dr Dean M Akiyama, Aquaculture Advisor, Indonesia presented on “Considerations for consistent quality shrimp feed production,” and discussed variance components analysis as a management tool for production. He stressed that current shrimp feed quality standards exceed the production facilities and farmer capability and that there has been no major innovations in shrimp feed and nutritional standards are fairly consistent. The takeaways highlighted the importance of palatability, uniform colour, size and water stability as well as managing protein and phosphorous levels in shrimp feeds.
Trond M. Kortner is Associate Professor at the Faculty of Veterinary Medicine, Norwegian University of Life Sciences. He began his presentation with four statements:
• Fish nutrient requirements are still far from being well defined.
• Even though we do not know the requirements, we are changing the diets. In Norway, salmon diets have changed from marine to plant ingredients over a short period of time.
• Production methods have been changing and moving to closed and intensive systems.
• Changes continue and research is running behind.
He began working on antinutrients in 2009, which was the time when aquafeed producers began focussing on plant materials, often in lieu of marine meals. Subsequently, feed formulators paid more attention on antinutrients, mostly present in plants, that somehow limit the intake of the feed or the availability of nutrients. These limitations can be at the level of intake, digestion, absorption, and/or metabolism. The possible harmful effects of antinutritional factors have been very well demonstrated in different fish species. In general, most will reduce fish growth performance and feed intake. They make the feed less efficient by binding with certain nutrients, making them less available. Overall, they affect the nutritional balance of the diet and feed conversion ratio in the long term.
“Therefore, to be able to produce fish feeds of high nutritional value to secure good health and welfare, detailed information of the presence and effects of antinutrients and adventitious toxins is required,” said Kortner. “However, most of the studies to date have been focussing on all raw materials and not on single purified antinutrients. This sets some limitations with regards to describing dose response considerations and to try to estimate maximum inclusion levels.”
The FAO database on anti-nutritional factors within feed ingredients is useful for feed formulators and nutritionists. Processing or treatments that may reduce impact of antinutrients are shown in Table 1.

In aquaculture, fish and shrimp are constantly exposed to pathogen pressures, environmental fluctuations and other production stressors, negatively impacting survival and productivity.
At dsm-firmenich, we offer solutions to protect aquatic animals, reducing the risk of health and welfare challenges throughout the production cycle.
We
Amylase
Lipase
Lectins
Phytic acid All plants Enzyme, mineral suppl.
Fibre
All plants
Enzyme, dehulling
Tannins Rape seed, beans Dehulling
Saponins Legumes
Sterols Legumes
Oestrogens
Beans
Gossypol Cotton seed
Oligosaccharides Legumes
Quinolozidine alkaloids Lupins
Goitrogens
Alcohol extraction
Alcohol/non-polar extraction, CH suppl.
Alcohol/non-polar extraction
Non-polar extraction, iron suppl.
Aqueous extraction
Aqueous extraction
Rape seed Iodine suppl.
Table 1. Processing/treatments that may reduce impact of antinutrients. (CHO=carbohydrates; CH=cholesterol) (https://www.fao.org/fishery/affris/feed-resources-database/anti-nutritional-factors-within-feed-ingredients/ en/)
Kortner covered specific examples for some of the main antinutrients important in aquaculture. With regards to protease inhibitors, the effects of purified soybean trypsin inhibitors in diets for Atlantic salmon have been well documented. “Nutrient digestibility decreased at levels above 4.5g/kg. when present at <5g/kg. most cultured fish can compensate by increasing their trypsin production,” said Kortner.
Lectins are present in most plant feed ingredients at 1-20g/kg, but extrusion inactivates the lectins to a large extent. There is more attention on glucosinolates since rapeseed meal is becoming a low-cost protein source although successful breeding has removed the glucosinolates.
The mode of action of phytoestrogens, present in beans, grains and seeds is to bind to estrogen receptors and interfere with reproduction and inhibit cholesterol uptake. Increased plant oil levels in fish feed increase the phytosterol: cholesterol ratio and Kortner cautioned that feed sterol profile should be monitored when using high levels of plant oils.

“One solution is using phytase enzyme and recent advances in phytase enzymology with improved properties give promise for increasing phytase applications in commercial fish diets.”
- Trond M. KortnerIn soybean and peas, Kortner explained that saponins affect emulsification and increase gut permeability. Saponins also affect nutrient absorption. The effect of purified saponin inducing enteritis in the distal intestine of Atlantic salmon was shown. “Salmon seems to be most susceptible. Normal distal intestine was observed in cobia, channel catfish, European seabass and seabream and some other species. In contrast, SBM induced enteritis has been reported in turbot, common carp, Japanese flounder, California yellowtail and pearl grouper.”
Present in all grains, beans, and most other plants, phytic acid is the most significant antinutrient in soy protein concentrate (SPC). It inhibits mineral absorption, causing mineral deficiencies. The increased use of plant protein in fish feeds has reduced mineral bioavailability. Discharge of phosphorus contributes to eutrophication and pollution of the water area. The phosphorus retention in Norway salmon production is only 25%. “One solution is using phytase enzyme and recent advances in phytase enzymology with improved properties give promise for increasing phytase applications in commercial fish diets,” said Kortner.
Adventitious toxins
These are elements and compounds that are not normal constituents of feed ingredients and can cause harm to animals. In essence, these are contaminants. The most relevant for aquafeeds include persistent organic pollutants (POPs); heavy metals (cadmium, lead, mercury, and arsenic); mycotoxins (aflatoxins, fusarium toxins etc.) and oxidised lipids, pesticides, and biogenic amines.
Kortner discussed the effects of mycotoxins in fish and commented, “The main mycotoxin is aflatoxin. Adverse effects range from organ damage (hepatic necrosis, branchial oedema, haemorrhage), impairment to the immune system, reduction in weight gain, metabolic alterations and reproduction disorders caused by zearalenone. Susceptibility to mycotoxins appears to be species specific.”
Dr Artur Rombenso , Senior Research Scientist and Animal Nutrition Team Leader at CSIRO, Agriculture and Food, Australia looked at how to harness some benefits of carbohydrates (CHO) in aquafeeds and in farmed systems. He noted that although an efficient energy source, carbohydrates are the least investigated among the macronutrients. This is because of its price and nutrient value.
Aquatic animals have a limited capacity to digest and utilise carbohydrates. Groupers do not tolerate carbohydrates. Dietary inclusion levels range from 1060% and are high in feeds for common carps and tilapia. Some sources of carbohydrates are given in Table 2.
described in several studies. Fish cannot cope with high glucose levels. In the salmon, an intake rich in carbohydrate results in impaired glucose homeostasis and growth retardation. “Therefore, more digestible sources will be an effective way,” said Rombenso.
The optimisation of carbohydrate utilisation is a complex subject. A study on carbohydrates in tilapia feeds showed that increasing NSP levels negatively impacted feed conversion ratio (FCR) and nutrient digestibility in terms of crude protein, fat and energy. While NSP is an energy source, it is an immune modulator with prebiotic effects from B-glucans, inulin, arabinoxylan oligosaccharide, mannan oligosaccharides, galactooligosaccharides and fructooligosaccharides.
Table 2. Some examples of carbohydrate sources and global production (Source: Kaushik et al., 2020)
Starch gelatinisation is important and many in the industry may not know the level of gelatinisation in the aquafeeds produced. Amylose and amylopectin play key roles. In fish feeds, expansion is needed to accommodate the oil component and therefore the amount of amylopectin is critical. In wheat the composition of amylopectin is 75% and in tapioca, 83%.
The suggested inclusion levels depend on the species requirement of the animal and whether the carbohydrate is used for sinking diets which require a minimum 10% starch or floating diets (minimum 20% starch). However, Rombenso indicated the formulator may add in what the animal needs, but can the diet be delivered with the processing methodology used?
Feed technology and carbohydrates inclusion
Aligning with technology, there can be little need for carbohydrates. In the evolution of salmon feeds, it was seen that in 1975, the first pelleted feed had 55% crude protein (CP) and 13% crude fat (CF). With extrusion and coating technology, this changed to 35% CP and 40% CF. In Mexico, novel technologies for pet feed using raw meat (i.e. chicken pulp) straight in the extruder preconditioner might be a promising solution to reduce the need for carbohydrates for those sensitive fish species.
With regards to shrimp feeds, acoustic feeders are changing the “normal” from what is regarded as the most suitable shrimp pellet. The feedback is that pellet symmetry and smoothness, integrity, water stability and solid pellets with less fines are critical characterisitcs. The formulation needs to be adjusted for pelleting or extrusion technology.
The impact of factors affecting digestibility of starch (highly digestible) versus varying digestibility with nonstarch polysaccharides (NSP) in fish species has been

“We can engage with more breeding companies to get the desired traits. We can also create acceptability of carbohydrates through early nutrition or nutrition programming.”
- Artur RombensoAt the animal level, the CSIRO team is attempting to further understand the animal and digestive physiology. Rombenso said, “Our knowledge in the carbohydrate space for aquatic animals is still less than that in livestock. We can engage with more breeding companies to get the desired traits. We can also create acceptability of carbohydrates through early nutrition or nutrition programming.”
At the plant level, we need to consider areas like breeding, processing and fermentation. “Research is in breeding new carbohydrate sources such as via gene silencing and editing but this could be sensitive and depend on country regulations. In Australia, consumers are averse to GM sources. In processing, it is reducing fibre, but the caveat is that with more processing of an ingredient there may be effects on the environmental profile and LCA scores of the ingredient. The CSIRO team is working on targeted fermentation and dual feeding where over the culture period, commercial feed is gradually replaced with fermented feed,” Rombenso explained further.
The takeaway message is to discover more on the multifunctional roles of carbohydrates in aquafeeds in terms of energy, functionality and beyond feeds, to boost natural productivity.
In managing gut health through nutrition, Dr Philippe Tacon , Product Manager - Microbials -dsm-firmenich introduced a new concept with postbiotics in aquaculture. In gut health, there is eubiosis versus dysbiosis (Figure 1). The improvement in disease resistance means better economic performance and animal wellbeing. A healthy animal means reduction in treatment costs

What are postbio9cs?
showed improved growth performance. Microbiome diversity increased. There was better survival and increased lysozyme and phagocytic activities when challenged with Vibrio parahaemolyticus (Ballantyne et al. 2023).
• In fish, postbiotics isolated from fish (cell-free supernatants and full suspension of bacteria isolated from mucus of skin, gill, gut of tilapia and rainbow trout), improved pathogen resistance. The significance of this study was that fermentation duration was important to ensure a positive effect. (Quintanilla-Pineda et al. 2023).
What are postbiotics?
Industry is familiar with prebio6cs which is a substrate selec6vely used by the host microorganism to produce a health benefit. There is probio6cs which are live microorganisms when added in adequate amounts, confer a health benefit to the host.
Lactobacillus product
ISAPP (Interna6onal Scien6fic Associa6on of Probio6cs and Prebio6cs) defines postbio6cs as “a prepara6on of inanimate microorganisms and/or their components that confers a health benefit on the host.˝
Tacon listed the components of postbiotics, all of which are involved in improving the efficacy to benefit aquaculture. As an example, Tacon discussed the components in heat killed bacteria Lactobacillus containing exopolysaccharides, bacterial fragments and cell free supernatant with bacterial DNA and metabolites with short chain fatty acids.
Industry is familiar with prebiotics which is a substrate selectively used by the host microorganism to produce a health benefit. There is probiotics which are live microorganisms when added in adequate amounts, confer a health benefit to the host. ISAPP (International Scientific Association of Probiotics and Prebiotics) defines postbiotics as “a preparation of inanimate microorganisms and/or their components that confers a health benefit on the host.˝
In July 2023, dsm-firmenich completed its acquisition of postbiotics pioneer Adare Biome. Tacon recounted the discovery of the pioneering postbiotic isolated from the human gut by Dr Pierre Boucard in France in 1907. Lactobacillus LB™ is a full postbiotic product comprising two unique and proprietary bacterial strains Limosilactobacillus fermentum and Lactobacillus delbrueckii . Tacon summarised studies on effects of LB in the tilapia and vannamei shrimp.
Philippe Tacon“It can be added directly into the feed. We do not need to be concerned on the viability of the cells when going through the pelleting process.”
Tacon listed the components of postbiotics, all of which are involved in improving the efficacy to benefit aquaculture. As an example, Tacon discussed the components in heat killed bacteria Lactobacillus containing exopolysaccharides, bacterial fragments and cell free supernatant with bacterial DNA and metabolites with short chain fatty acids.
Why are postbio9cs of interest in feeds?
• In Egypt, in 35g tilapia fed LB 2x109/kg of diet showed improvement in weight gain and feed conversion ratio. Challenged with Aeromonas hydrophilia, LB improved survival and immune response (white blood cell count, phagocytic index, nitric oxide release, Sherif et al. 2014).

The efficacy of postbio6cs has been proven and the ac6ve form is present in the feed. As all of the metabolites have been released in the fermenta6on media, effec6veness does not depend on viability of bacterial cells. Furthermore, there is the convenience and safe aspect.
“It can be added directly into the feed. We do not need to be concerned on the viability of the cells when going through the pelleting process.”
- Philippe TaconWhy are postbiotics of interest in feeds?
The efficacy of postbiotics has been proven and the active form is present in the feed. As all of the metabolites have been released in the fermentation media, effectiveness does not depend on viability of bacterial cells. Furthermore, there is the convenience and safe aspect.
“It can be added directly into the feed. We do not need to be concerned on the viability of the cells when going through the pelleting process. We have control on the number of bacteria as during the fermentation, we stabilise them during the heat treatment.”
It is safe to use. Tacon noted that there is no bacterial movement from the intestinal lumen to the bloodstream, i.e. no known risk of bacteraemia or fungaemia and no known acquisition or transfer of resistance to antibiotics.
Tacon discussed recent studies on postbiotics with vannamei shrimp and tilapia.
• In Belgium, 0.64g SPF L. vannamei fed diets containing LB (g/kg feed) at (0.2g and 0.5g) showed improvements in feed conversion ratio, survival to 75% and specific growth rate after 4 weeks. The dose was increased to 10g LB/kg in a challenge with white spot syndrome virus (WSSV) and shrimp showed improved survival against WSSV at the highest dose (Figure 2).
• In China, 80g tilapia were fed diets formulated with LB at 0.01%, 0.02% and 0.3%. When challenged with Streptococcus agalactiae, cumulative mortality declined after 14 days of feeding.
• L. vannamei of approximately 5mm each, were randomly fed diets formulated to contain concentration of LB at 0.05%, 0.1%, 0.2% and 0.3%. When challenged with V. parahaemolyticus, at 6.8 × 107 CFU/mL, cumulative mortality declined at the higher dosages after 14 days feeding.
Tacon concluded that there is proven efficacy for postbiotics in aquafeeds such as growth performance and disease resistance. However, more research needs to be done on the identification of metabolites such as the genome of bacteria and potential metabolites they release as well as to learn more on microbiome in aquatic animals.

• Litopenaeus vannamei fed heat-killed postbiotic Pediococcus pentosaceus at two concentrations
• In China, 80g 6lapia
diets
with LB at 0.01%, 0.02%
0.3%. When challenged with Streptococcus agalac7ae, cumula6ve mortality declined ager 14 days of feeding.
• L vannamei of approximately 5mm each, were randomly fed diets formulated to contain concentra6on of LB at 0.05%, 0.1%, 0.2% and 0.3%. When challenged with V
The actual palatability of shrimp feeds is related to consumption levels in production ponds during operations
By Dean M Akiyama
Source:Eap et al., 2020.
Shrimp are aquatic poikilotherms and their physiological processes are directly influenced by water quality parameters. These would include temperature, dissolved oxygen(DO), salinity, and pH fluctuations. These water quality parameters along with animal health status will directly affect feed consumption and nutrient availability. These parameters will also constantly be changing during the day and night cycles.
Low DO and low water temperatures directly reduce shrimp appetite and feed consumption levels. If DO in the morning is low, there will be low feed consumption. However, as DO and temperature increase during the day, shrimp appetite will increase. DO levels always should be more than 6ppm. Lower DO levels will stress but do not necessarily kill shrimp; however, the growth rate will be reduced. The ideal temperature for shrimp growth will be between 28-32°C (Akiyama, 2022).
Feed conversion ratios (FCRs) are influenced 60-70% by pond management (Akiyama & Yukasano, 2022). To achieve good FCRs, when to feed shrimp and feeding the correct amount at any given time are more critical than feed quality. As we cannot control the outdoor environment, we cannot accurately determine shrimp feed consumption at any given time. Thus, it is critical to have the proper amount and combination of appropriate attractants and palatants to maximise feed consumption. This is essential for shrimp feed regardless of the environmental conditions and/or the physiological status of the animal to ensure maximum feed consumption.
Attractability is a chemical reaction where soluble nitrogen components leach from the feed and stimulate shrimp feed searching behaviour. This reaction is for immediate feed detection and for location of the feed from considerable distances. These chemoreceptors are in the
antenna and pereiopods of shrimp. Attractability will not necessarily incite feed consumption.
Palatability is the capacity of a feed to stimulate shrimp appetite and feed consumption. Palatability receptors are found on the mandibles of shrimp (Figure 1). Continuous and maximum feed consumption requires a combination of both attractants and palatants. The term palatability enhancer will be used to describe attractants and palatants in combination.
It is commonly known that small nitrogenous compounds (amino acids, amines, peptides) are palatability enhancers. A combination of various nitrogenous compounds is a stronger palatability enhancer compared to a single compound. Some carbohydrates and lipid fractions may enhance palatability as these are natural products of organic decay and consistent with the omnivorous and scavenging feeding habits of shrimp.
We also need to avoid using anti-palatability ingredients. These ingredients will reduce feed consumption and in more severe cases, cease feed consumption altogether. Some examples of these anti-palatability ingredients include formaldehyde binders, volatile fatty acids supplements, old and rancid marine animal meals, rancid fish oils, saturated fats, etc.
The feed pellet characteristics can influence feed consumption. If a feed pellet does not absorb water and swell, it will reduce feed consumption. It will also reduce the levels of palatability enhancers from leaching out of the feed pellet. The proper feed pellet size for the different sizes of shrimp will also affect feed consumption.
The homogeneity of the feed mixture is extremely critical so that every feed pellet has some palatability enhancer. The smaller the pellet size, the higher the level of palatability enhancer is required in the formula. A shrimp feed pellet of 1.8mm diameter and 2.0-3.0mm length will have 170 pellets per gram. A 20g shrimp with a feeding rate of 1.8% body weight per day will consume only 0.36g of feed. Thus, the minimum amount of feed ingredients that contains palatability enhancers should be 10% of the feed formula to ensure proper feed mix. The more feed consumed, the faster the shrimp will grow. If all feed pellets are eaten, there will be less pond waste and a more stable water quality.
Feed consumption is influenced by factors such as level of attractants, level of palatants, as well as size and texture of feed pellets. Ingredients such as fishmeal, marine animal meals, marine solubles and hydrolysates
are often used as palatability enhancers, ensuring that shrimp find the feed appealing and consume it readily. Balancing the various types of palatability enhancers and maintaining minimum levels will ensure essential nutrients are consumed with every feed pellet. Enhancing feed consumption is crucial for promoting feed intake, growth, and overall performance criteria in shrimp. Various natural and synthetic compounds may be used to improve the attractability of shrimp feeds.

Monitoring feed consumption with feed trays. If all feed pellets are eaten, there will be less pond waste and a more stable water quality.
Total solubility is used as an indicator for palatability enhancer level (Table 1). This is a simple and fast method for determining the palatability enhancer level in every batch of marine animal ingredient received (Appendix 1). Every batch of marine animal ingredient should be measured for total solubility as the level of total solubility will vary in all feed ingredients by production batch. This value should be added to the feed ingredient database as an essential nutrient. Ideally nitrogen solubility should be analysed for every batch of marine animal feed ingredient, although nitrogen analyses are time consuming and expensive to do routinely.
Unfortunately, there is more research and understanding of palatability enhancers for fish and very limited information in shrimp. In fish, there are definitely species differences for the type and amount of palatability enhancers required. Although we can assume that there will be species differences for shrimp, the levels and
types of palatability enhancers are still undefined. The vannamei shrimp is an active and fast feeder. In contrast, monodon shrimp is a slower deliberate feeder. It is recommended that the minimum level for total solubility for vannamei shrimp is 6% and the minimum level for total solubility for monodon shrimp is 8%.
These levels can be established as a least cost restriction variable to ensure that all shrimp feed formulations will have the minimum required amount of palatability enhancers in the least cost formulation. Though there are regional and country differences for the availability and cost of various shrimp feed ingredients, setting a minimum level of palatability enhancer as a restriction will be a cost item similar to available phosphorus. The correct level and type of palatability enhancers encourage consistent continuous feed consumption, which in turn support the health and growth of the shrimp in aquaculture production systems.
The level and types of palatability enhancers will be determined by market standards and will depend on shrimp production systems, availability and price of palatability enhancers and shrimp feed processing conditions. The above recommendations are for pelleted shrimp feeds. Extruded shrimp feeds will definitely have different criteria for consideration.
A true measure of the efficacy of shrimp feed palatability enhancers is the actual consumption in production ponds during operations. It is important to maintain optimal pond conditions; parameters such as DO, temperature, pH, phytoplankton, organic solubles, need to be factored in when comparing feed consumption between feeds. The protocol for testing comparison of two feeds for feed consumption levels in production ponds is given in Appendix 2. This protocol can be used to determine the feed consumption of new formula compared to existing formula or comparison with competitor feeds.
There are many misconceptions in shrimp production regarding feed management. Feeding tables are well established but can only be considered as guidelines. Feeding tables cannot reflect real shrimp feed consumption at any time given the fluctuations in water quality and animal health status of the shrimp which are constantly changing.

Feeding tray observations are only “guesstimates” for that specific time of feed application.
Feeding tray observations are only “guesstimates” for that specific time of feed application. Feed consumption algorithms are being developed with considerations for temperature, DO, pH, salinity, bacteria count, etc. This will have better feed consumption estimates with limitations. The measurement of these parameters will be done the previous day and/or previous sampling period, but not in real time for feed distribution.
Auto feeders are routinely used and if effectively managed, may be better than manual feeding. Feeds can be given in smaller amounts and at higher frequencies/day as compared to hand broadcasting. Autofeeders will help as more feed is consumed with less feed waste, promoting stability in water quality.
However, the “game changer” is estimating real-time feed consumption similar in salmon farming. When shrimp are eating feed, more feed will be given and when shrimp stop eating, feed distribution will stop. Real-time feed consumption management will change the shrimp feed requirements.
Feed formulations will need to be adjusted as feed is being consumed with shorter exposure to water. If water quality is better managed through feed consumption, the nutrient densities can be increased which will ultimately result in lower FCRs. The feed processing conditions will need to be adjusted to produce more durable feeds with the right textures.
Consequently, perhaps shrimp pellet sizes will need to be adjusted to feed consumption levels for different sizes of shrimp.
Feeding behaviour and feed consumption are complex entities with a variety of factors affecting palatability. Raw material quality, feed processing conditions and formulations all affect attractability and palatability of aquafeeds. Palatability enhancers allow the nutritionist some flexibility with raw material restriction for shrimp feed formulations.


Links for Appendices
Appendix 1 - Determination for total solubility in raw materials. https://bitly.ws/3e6rR
Appendix 2 - Shrimp Feed Attractability/Palatability Trial in Production Ponds -Comparison of two different feeds. https:// bitly.ws/3e6rG
References
Dean M Akiyama. 2022. Beyond the hatchery. Aqua Culture Asia Pacific, March/April 2022, pp8-12. https://bitly.ws/3bcLy
Dean M Akiyama and Dany Yukasano. 2022. Shrimp feed management in outdoor ponds for Litopenaeus vannamei. Aqua Culture Asia Pacific, July/August 2022, pp30-37. https://bitly. ws/3bcLm
Eap D, Correa S, Ngo-Vu H, Derby CD. 2020. Chemosensory basis of feeding behavior in Pacific White Shrimp, Litopenaeus vannamei . Biol Bull. 2020 Oct;239(2):115-131. doi: 10.1086/710337. Epub 2020 Sep 15. PMID: 33151752.

Dean M Akiyama, PhD is an Aquaculture Technical Advisor, Indonesia. Email: akiyamadm@gmail.com
The Asian seabass Lates calcarifer is a popular highmarket-priced fish in Bangladesh, where the supply is mainly from coastal fisheries and usually marketed as fresh or live. Currently, there are some mixed cultures of fish in ponds with carp and shrimp. Fingerlings are primarily wild caught, although very recently, there were some imports from Thailand. A major challenge is that the seabass has not adapted to commercial fish feeds in culture ponds, so the farmer feeds the seabass with live fish, crabs, tilapia, and mullet.
A recent initiative by the Greenhouse Mariculture team is to push for its culture in ponds. But first, it needs to close the cycle for the Asian seabass in Bangladesh and lay out the technology for pond culture. Success came at the end of 2023 after two years of work. At the recent Giant Prawn 2023 held in Bangkok, Thailand, from November 29-30, Md Modabbir Ahmed Khandaker, Consultant at Greenhouse Mariculture and Mohammed Tarique Sarker, Managing Director, Fishtech Hatchery Limited, detailed their wishes and current progress with their projects to advance seabass farming in Bangladesh.

Md Modabbir Ahmed Khandaker has been consulting for Greenhouse Mariculture for this seabass hatchery project since in 2021. He is also a veteran shrimp hatchery consultant marketing Artemia in Bangladesh. In 2011, he introduced soft-shell crab farming to farmers in Bangladesh.
Wild in lieu of the domesticated broodstock
“There is a lot of interest in the Asian seabass. It is one of the most expensive fish in Bangladesh. For almost 20 years or more, many teams in Bangladesh, including those in government and non-governmental organisations, have been trying to produce seabass fingerlings. Two years ago, we started planning for an indoor hatchery to produce fingerlings for commercial farming in Bangladesh, using a recirculation aquaculture system (RAS). We sought assistance on hatchery technology from producers in several countries: Sri Lanka, India, Thailand, and as far as Australia. Now, we are delighted to announce our progress in the hatchery for this species. More importantly, is that we have the first RAS for broodstock management in Bangladesh.”
The first hurdle was the challenge of importing broodstock into Bangladesh. “Although it was more difficult to handle wild broodstock, we had to resort to rearing the captured fish from our coastal waters. We kept them for 10 months in large broodstock tanks, initially feeding them live shrimp, gradually adapting them to dead shrimp/fish, and then the formulated feeds. In their natural habitat, most male seabass is under 4kg body weight. Subsequently, sex reversal to females starts in larger fish,” said Md Modabbir. As a protandrous hermaphrodite, Asian seabass initially sexually mature as males at 2–3 years (2–4 kg body weight) before their sex changes to female at 4–6 years (6-8kg) (Ayson & Ayson, 2013).
“Following the manipulation of maturation with hormones, spawning was successful. This is a first in the history of Bangladesh. Now, we have 25-day-old fingerlings. We are weaning them on to artificial diets. As I mentioned, a problem with using juveniles from wild broodstock is that fish remain very carnivorous and will only feed on trash fish and live tilapia, shrimp, and crabs. We want to change this and, during grow-out, feed fish on extruded feed,” stated Md Modabbir.
Their success is the production of one million eggs, of which 0.5 million were fertilised. The hatching rate was 95%, giving the team 0.45 million larvae. In November, Md Modabbir said that the hatchery produced 0.3 million 25-day-old larvae, giving a survival rate of more than 60%. He updated on further progress. By the end of January, the production was 0.12 million juveniles (average weight 1.76g/fingerling) and sold more than 50,000 fingerlings.
“We did not face any big challenges during our rearing periods, apart from some environmental fluctuations. Fluctuations in seawater salinity, temperature, pH, etc. posed some problems during the rearing cycle. We did face some problems in maintaining live feeds (rotifer) culture because of the abundance of ciliates.”
AUGUST 14-15, 2024
Networking & Engagement Opportunities!


•
BANGKOK, THAILAND
Don’t miss Asia’s leading aquaculture event! Save the Date!
While there are large and successful integrated operations making waves globally, most stakeholders in Asia are still seeking focus and directions for growth. Production in Asia is still associated with lower value fish such as the tilapia and pangasius, and there is no significant marine fish species. Asia has lagged its temperate species peers in the past decade. Why is that and what is holding it back?
TARS 2024 offers expert analysis, business models, technology, innovations and state- of- the-art- biotechnology, and a deep dive into challenges along the entire supply chain – from genetics to production to marketing.
• State of the Industry and Challenges
• An Early Start with Genetics, Hatchery and Weaning
• Disease Mitigation: Management and Innovation
• Back to Basics and Nutrient Focus Feeds
• Feeds Fit for Environmental Security and Human Health
• Future Proofing Asia’s Finfish Aquaculture
Industry challenges = startup opportunities = venture capital investments

Registration opens on March 20
Marketing, Branding and Sustainability: A Global Exchange Seats limited to 250 participants
Industry Panels, Q&A and more!
INTERACTIVE BREAKOUT ROUNDTABLE SESSIONS on how to build an integrated enterprise A BETTER TILAPIA
PANGASIUS: TRACEABLE & SUSTAINABLE
Now in its 13th year, The Aquaculture Roundtable Series® (TARS) is a stakeholder-driven effort to facilitate the sharing and exchange of information and experiences for a common goal, to equip the industry with the next phase of growth.
Organisers

MASS MARKET MARINE FISH
For more information, Email: conference@tarsaquaculture.com www.tarsaquaculture.com
Follow us on
Sponsors
Finally, we want to export the fish, as there is demand for seabass internaConally All these are in line with the government’s strategy to start mariculture in Bangladesh.”

“Next for us is to deliver the juveniles to farmers for grow-out, develop feeds and disseminate the technology of nursing the fry. We will use some fingerlings for our own farms and grow out the fish. Finally, we want to export the fish, as there is demand for seabass internaConally All these are in line with the government’s strategy to start mariculture in Bangladesh.” Grow
once we manage to spearhead seabass farming in ponds and cages, we expect to produce our own seabass feed. We also understand the off-flavour issue in seabass reared in ponds. This may be unacceptable to consumers used to consuming wild seabass. So, the next step is to develop cage culture. We may look at the possibility of using lined ponds to overcome this offflavour problem.”

AnCclockwise: From broodstock, to
AnCclockwise newly hatched larva larvae

Anticlockwise: From broodstock, to newly hatched larvae to 25day old juveniles.
With the above success, both expect that seabass culture will take off in Bangladesh. The interest in seabass culture also comes from a desire by traditional and semi-intensive shrimp farmers to have an alternative species for their ponds, particularly during these times with low farmgate prices. Tarique said there are many abandoned shrimp ponds because shrimp farming is no longer profitable. “Farmers need juveniles, feed and nursing and culture technology.”
Tarique Sarker chipped in that he is running grow-out trials with some two-month-old juveniles imported from Thailand with five farmers. “Culture is only around two months. We are using feeds from Growel Feeds in India, but in the future, once we manage to spearhead seabass farming in ponds and cages, we expect to produce our own seabass feed. We also understand the off-flavour
Tarique Sarker chipped in that he is running grow-out trials with some two-month-old juveniles imported from Thailand with five farmers. “Culture is only around two months. We are using feeds from Growel Feeds in India, but in the future, once we manage to spearhead seabass farming in ponds and cages, we expect to produce our own seabass feed. We also understand the off-flavour
“Next for us is to deliver the juveniles to farmers for growout, develop feeds and disseminate the technology of nursing the fry. We will use some fingerlings for our own farms and grow out the fish. Finally, we want to export the fish, as there is demand for seabass internationally. All these are in line with the government’s strategy to start mariculture in Bangladesh.”
Tarique Sarker chipped in that he is running grow-out trials with some two-month-old juveniles imported from Thailand with 5 farmers. “Culture is only around two months. We are using feeds from Growel Feeds in India, but in the future,
“Current prices are high at almost USD4/kg for size one kg fish. These are usually sold in restaurants. Larger fish of 2-3kg fish are sold at USD6/kg.” Tarique clarified that frozen fish is not popular in Bangladesh. “Furthermore, seabass is euryhaline and can be cultured in 0-35ppt salinity. Here in Bangladesh, we have lots of coastal and inland waters. If the government and private sector can work together, we can have a very successful industry.”
Reference
Evelyn Grace de Jesus-Ayson and Felix G Ayson. 2013. Reproductive Biology of the Asian Seabass, Lates calcarifer in book: Biology and Culture of Asian Seabass Lates calcarifer (pp.67-76) DOI:10.1201/b15974-5
 Indoor RAS facilities for larval and nursery rearing and broodstock management.
Indoor RAS facilities for larval and nursery rearing and broodstock management.
In Suthi Mahalao’s Boonsawang farm, the mark of success is when his seabass is accepted by Japanese chefs in Bangkok

Over the last 10 years, Suthi Mahalao has been a happy man. He owns the Boonsawang farm in Bangpakong, Chachengsao Province which has an annual production of more than 700 tonnes of Asian seabass, Lates calcarifer giving a yield of 22.3 tonnes/ha from the 31ha farm. This has been continuous for over 10 years. However, the actual capacity is more than 1,000 tonnes/year, but production has been restricted by demand. Acceptance in high end retail markets is recognition that his seabass production is natural and free of chemicals and antibiotics.
Suthi is not only well known for his farming skills but also as the inventor of a grading bucket now adopted by farmers in Thailand. He has also trained farmers in using pelleted feeds in seabass farming. He is the current chairman of the Thai Marine Fish Farming Association and has received as many as 20 accolades for his contribution to Thailand’s aquaculture industry. Among them are Best Fish Farmer in the Royal Ploughing Ceremony Year 2017, Lert Rat Award in 2018 and Best Fish Farmer of the National Bureau of Agricultural Commodity and Food Standards, Thailand.
It is well known that the most discerning buyers are Japanese chefs. Success is when inland cultured seabass meets these chefs’ criteria on quality and freshness. Boonsawang supplies seabass fillets to premium restaurants in Thailand such as the Kensaku Japanese restaurant and premium Copper Buffet where seabass is prepared as sashimi. The farm also supplies fish for Thai raw fish “Ikejime” (Ikejime is a method of killing fish which maintains the quality of its meat). This was possible as the farm’s seabass has passed the test of no off-flavour or muddy taste.
The farm harvests 800g fish and will also harvest 5-6kg fish for special markets such as for the Ikejime preparation. Current farmgate prices are THB120kg (USD3.4) for live fish. For chilled fish, prices (in THB) are 80/kg for 400-600g fish; 90/kg for 700-800g fish; 80/kg for 900g-1kg fish; 70/kg for 1.2-2kg fish and 110/kg for 2.23kg fish. The exchange is THB 9.66 for one USD.
Generally, consumers prefer farmed seabass in sea cages rather than those farmed in earthen ponds, mainly because of off-flavour in pond-raised fish. Boonsawang farm prefers to culture fish in earthen ponds with 15-18ppt salinity. It is also easier to manage because of Suthi’s farming experience. He has found ways to address weak points in inland pond culture such as off-flavour, taste, texture, and quality (Figure 1).
The farm starts with 5-inch (12.7cm) fingerlings. Stocking density will depend on target harvest sizes. For harvests of 500g fish, it is 5 fingerlings/m2; for 1 kg fish, it is 3 fingerlings/m2 and for larger fish, it is only 1 fingerling/m2 In general, he says that the stocking density is 3-4kg/m2
The nursing area is 30% of the farm area and is used for the first month stocking. Fish are disinfected before stocking to be parasite- and pathogen-free. Fingerlings come from a hatchery, which is a member of the Thai Marine Fish Farming Association. Prior to delivery, the hatchery will acclimatise fingerlings to the salinity of pond water at the farm and temperature during transportation is 25-26°C.
Water preparation should be at least a week before stocking. Water is filled to the optimum level and the aerator requirement is 1 HP/tonne of biomass for adequate oxygen demand. The optimum water parameters should be, pH 7.5-8.5, alkalinity >100ppm, transparency 1020cm, salinity 15-30ppt, and ammonia nitrite 0. The survival rate is more than 80% for the 6-month cycle. The average daily growth or ADG is around 5.4g.

Suthi Mahalao, owner of Boonsawang farm in Bangpakong, Chachengsao Province is current chairman of the Thai Marine Fish Farming Association and has won 20 accolades for his contribution to Thailand’s aquaculture industry.
A harvest of seabass at Boonsawang farm.
Suthi first entered aquaculture in the farming of the monodon shrimp in 1992, as well as acting as a feed distributor. His journey into seabass farming has not been without challenges. In 1995, he began seabass farming using fresh feeds, but he failed. A year later, with the availability of slow sinking feeds, together with another farmer, Suthi continued to farm seabass but again failed. While other farmers left the industry, he persevered with slow sinking pelleted feed, achieving a survival of 20%. He said, “The fish did not look like the seabass but more like a tilapia with a short and plump body. Over the 2 years, I lost USD30,000. I then stopped farming and over the next 8 years, decided to visit farms and learn fish farming from about 300 farmers. In 2004, I restarted, and success came on a yearly basis.”
In a discussion, Suthi identified some techniques which led to his success in seabass farming. It began with him identifying the feeding behaviour of fingerlings and dividing them into five groups. Depending on the feeding behaviour, he will adjust the feeding protocol. In 2004, he was the first farmer to wean 1 inch (2.5 cm) fish onto artificial feeds. He has also modified the feeding rate and management based on fish behaviour i.e., slow and aggressive feeders and

those that reject feeds. He has studied the size of feeds required over the culture cycle. The industry uses 4-5 sizes of feeds. Together with Thai Union Feedmill, Suthi has developed 10 sizes of pellets for his farm. The largest size range is 23-30mm.
The broadcasting of feed is in the shape of a traditional Chinese fan with regular speed and force. Feeding is only conducted during low light, i.e., early morning and late afternoon. This is because, according to Suthi, fish are afraid of bright and strong sunlight. He does not use any auto feeder as he wants the feeding team to observe the condition of the fish, understand how to feed and take care of the stock. He also continues to run the aerator during feeding to ensure dissolved oxygen (DO) is sufficient when fish are digesting feed. Attention is on feeding as sometimes fish overconsume when they are stressed.
In general, the feeding protocol includes no feeding over the 2 days after stocking and on the third day, they are fed only for the morning meal. Feeding is within the feeding frame with a blue net with a perimeter of 50m. Broadcasting of feed is aligned to the wind direction and is completed within 10 minutes. Feed amount is 90% of feed demand according to biomass. The team dissects fish and examines left over feed in the fish stomach, identifies sizes of pellets and adjusts feeding accordingly. Some feed conversion ratios (FCR) are shown in Table 1.
Suthi has studied in detail soil and water parameters and their management so that he can operate the farm successfully with the principle of “prevention is better than cure.” His technique of pond preparation is a mechanical way of using only water. This is essential so that fish cultured in these ponds have no off-flavour. This is done by switching between dry and wet soil conditions multiple times to eliminate bacteria, snails or weeds and use chain dragging to refresh the pond bottom.
Pond water colour is maintained at light green.

Pond preparation is over 50 days and starts with drying the pond after harvesting until the pond bottom cracks. The pond is then filled with water to a depth of 60cm in the deepest part of the pond. Aeration is for 2 days using a long arm aerator and with 10 dosages of effective microorganisms (Bacillus probiotics) which is also used during the culture period.
Next is chain dragging continuously over 20 days. This is done twice a day, each for 2-3 hours per round during the early morning and evening. This is to stir up all the sediments and mix them with water. According to Suthi, on day 3, toxic gases will burst out creating a stinky, black, and oily surface and on day 7-10, there will be more gas emissions. On day 11-12, the water colour will change from black to gray and by day 15-17, brown bubbles will surface. If this does not happen, it is time to add microorganisms.
From day 18-20, the farmer should examine the soil to ensure cleanliness. Chain dragging is repeated if there is still black soil. Drying will follow until the soil cracks on day 21-22. He cautioned that it may be necessary to repeat chain dragging or extend the process, if at the last crop, there were parasites. Next is to apply lime at around 400500kg/acre (1,000-1,235kg/ha), followed by spraying
with water and leaving overnight to reduce the bacteria population. Water is then added very slowly to fill up the pond and to cover only 10cm in the shallow area.
Suthi said, “Inland farming can be better once the farmer learns how to manage the farm properly. What we need is knowledge and know-how. I am always happy to share my experiences and knowledge with anyone with a passion to learn. I love farming fish and sharing what I learnt is important for me.”
“To feed the world with farm seafood is becoming more important and a farmer must value his or her contribution. It is essential to feed our fellow human beings with safe and quality fish. This is our responsibility.”

Soraphat Panakorn is Aquaculture Technology specialist of Novonesis and Vice President of Thai Aquaculture Business Association (TABA).
Email: january161975@gmail.com
 The grading bucket, developed by Suthi Mahalao now adopted by farmers in Thailand.
Harvesting seabass at Boonsawang farm.
The grading bucket, developed by Suthi Mahalao now adopted by farmers in Thailand.
Harvesting seabass at Boonsawang farm.
A Q&A with UMITRON’s Ken Fujiwara on his aspirations for remote sensing
In the realm of aquaculture, satellite data has emerged as a transformative force, shaping the industry’s dynamics and sustainability. At UMITRON, a leading player in this space, the conversation extends beyond the routine discussions of satellite data’s current applications. This article gives the visionary perspectives of Ken Fujiwara, CEO and CoFounder. He shares insights into the company’s inception, the pivotal role of satellite technology in addressing industry challenges, and his vision for the future, where satellites play a central role in sustainable aquaculture.

Ken Fujiwara, CEO and Co-Founder of UMITRON which began in 2016. This is a Singapore and Japan based deeptech company with a mission to empower aquaculture through technology. It builds user-friendly data platforms for aquaculture by using IoT, satellite remote sensing, and AI to enable farmers to improve farm efficiency, manage environmental risks, and increase business revenues.
What inspired you to set up Umitron?
While working as an aerospace engineer developing earth observation satellites and looking at images of Earth, the realisation that our planet is predominantly covered by oceans sparked the idea of contributing to marine environmental conservation and sustainable food production. Our company’s mission is to “install sustainable aquaculture on Earth,” addressing challenges in the aquaculture industry and the marine environment.
What are the primary challenges faced by the aquaculture industry that satellite technology can address?
The industry grapples with volatility influenced by water quality, diseases, and market demands. Satellite technology, particularly remote sensing data, offers a solution by monitoring ocean conditions. This data makes aquaculture operations more predictable and repeatable, mitigating risks associated with excess or shortage of harvest, workforce, and feed.
In Japan, Umitron engineers integrated the buoys into the PULSE platform, allowing farmers in Ehime to access comprehensive data insight, which empowers farmers to make better-informed decisions about feeding, treatment, and asset protection in the event of inclement weather. Ultimately, it will enable them to achieve more with less. Pulse also has an Enterprise tier, where Umitron used up to 30 years of historical data and AI models for projects such as blue carbon mapping, site spatial planning and risk reporting.
How do satellites currently support aquaculture practices?
Satellite use and the resulting data have been crucial in providing insights across a few areas in aquaculture, from site selection and environmental assessment to dayto-day farm operations. Aquaculture projects typically start with finding a suitable site for farming, and satellite data is used for mapping coastal areas and checking the surrounding environment. Once this first stage is established, more detailed environmental assessments and decades of historical environmental data can be used to assess suitability for fish, facilities, and operational safety. During farming operations, real-time data and forecasts of critical parameters such as temperature contribute to optimising feed amounts, and oxygen and chlorophyll data support risk mitigations to reduce the mortality rate of fish. We plan to add more local data by collaborating with local governments and public research institutes.”
How do you anticipate satellites evolving to enhance the aquaculture sector in the next 10-20 years?
The aerospace industry’s recent and continued shift from one large satellite to multiple small satellite constellations will revolutionise aquaculture. Increased frequency of real-time ocean observation and high-speed internet connectivity in coastal to offshore regions will make operations more predictable, repeatable and accurate. Ultimately, aquaculture operations in remote areas using accurate marine environmental forecasts and enhanced global connectivity will become a reality.
What are Umitron’s goals and how can we use satellite technology in achieving them?
While human colonisation is possible on other planets in the future, I believe that most of the 10 billion people will continue to live on Earth. Umitron envisions providing ample food for Earth’s growing population while maintaining healthy oceans through sustainable aquaculture. As we continue our journey on “spaceship Earth,” understanding and responding to global challenges become paramount. Satellite technology is instrumental in achieving this goal by offering timely insights into oceanic changes, enabling swift and timely action on a global scale.

Figure 1. PULSE is an advanced satellite monitoring tool aggregating data from over 30 satellites and open-source data for crucial ocean parameters, such as dissolved oxygen, chlorophyll A, salinity, wave height, and water temperature. It integrates various ocean environment data and provides one-stop access to ocean environmental data, which typically are stored and hosted at multiple websites and less accessible for farmers for daily use. It enables users to view historical data of up to two years and forecast data of up to 48 hours for their site.

The team at Umitron is passionate about advancing innovation and sustainability in aquaculture. One of the ways they have been doing this is via PULSE, a webbased platform integrating data from over 30 satellite sources and buoys worldwide with its AI models to deliver daily insights into ocean conditions across 7 data parameters (Figure 1).

global
covers every stage of the supply chain - from the entire feed production process to post harvest. A

Managing Multi-Species Marine Finfish with Primary Ectoparasites Pathogens of Diseases in Floating Cages
Author: Leong Tak SengPublication date: April 2022, 73pp
Book Review:
ISBN 978-967-13028-1-1
This is the second book covering diseases in multispecies marine fish by retired professor Leong Tak Seng, PhD. Leong has spent his entire scientific and industry career in marine fish disease management. He joined the School of Biological Sciences, Universiti Sains Malaysia (USM) in 1975 and retired as a Professor of Parasitology at the School in 1998. The first book published in 2014 was on “Parasites and Diseases of Warm Water Marine Finfish in Floating Cage Culture.”
In Asia, mariculture began in the early 1970s and grew rapidly in the late 1980s with the success of hatchery-
produced marine fish fry in Taiwan, Thailand and Indonesia. Most of the floating cages, culturing multi-species marine finfish, are located along the coastal regions. Initially, culture was of wild caught fingerlings of estuary groupers Epinephelus coioides and golden snappers Lutjanus johni. Disease outbreaks soon occurred after their introduction into cages. The epidemiology of parasites and diseases in marine finfish culture in floating cages began in the mid-1980s at Universiti Sains Malaysia, Penang, Malaysia.
The book is divided into nine chapters. The first two are general information on fish cultured in floating cages, the diversity of fish species, grow-out production cycles, status and diseases problems in fish farms. There is also a discussion on the stress factors, and do stresses cause fish disease outbreaks? Chapter 3 covers freshwater treatments of diseases and chapter 4, deals with freshwater treatment of ectoparasites in healthy fish and during disease outbreaks.
Chapters 5 and 6, cover the effect of use of hydrogen peroxide treatment on ectoparasites on healthy fish and some miscellaneous problems encountered during the studies. Chapter 7 gives a summary of these studies and an attempt to determine the primary ectoparasitic pathogen(s) that cause disease outbreaks. Chapter 8 provides standard operation procedures for floating cage farms.
“Initially fish disease symptoms observed in floating cages through 1985 to 2013 were similar in all fish species cultured. The basic question is, what is or are the primary ectoparasites pathogen(s) that initiate these disease outbreaks? We then started monitoring studies between 2015-2018 in a floating cage farm in Penang to determine the above question(s). These studies were different from other monitoring studies in that only ectoparasites Benedenia/ Neobenedenia spp., leech Zeylanicobdella arugamensis and parasitic copepods Caligus spp. populations on the body surface were examined from freshwater treatment on all fish cultured in a cage. Ectoparasites on the gills were not examined as fish have to be killed for the study,” said Leong in the preface.
The information in this book is useful for fish farm owners, fish health consultants, fish parasitologists and pathologists and diagnostic laboratories. More information: leongtakseng@gmail.com (Leong Tak Seng).
May/June 2024
Issue focus: Sustainable & Responsible Aquaculture
Industry Review: Aquafeed Production
Hatchery Technology
Deadlines:Articles/Adverts – March 20
Special Distribution at Asian Pacific Aquaculture (APA) 2024, July 2-5, Surabaya Indonesia
July/August 2024
Issue focus: Demand & Supply Equilibrium
Industry Review: Tilapia
Novel Ingredients
Deadlines: Articles/Adverts – May 13
Special Distribution at TARS 2024, Finfish Aquaculture, August 14-15, Bangkok, Thailand; AQUA24, August 26-30, Copenhagen, Denmark
Email: zuridah@aquaasiapac.com/enquiries@aquaasiapac.com
Production trends at the global meet on the giant freshwater prawn

There is a long history to this global meet. Forty-three years ago, Michael New, as FAO Project Manager based in Bangkok, organised the first Giant Prawn conference in 1980 with DoF. New is the patron for GP2023, as well as coeditor for the publication of papers from this event. In his message to the attendees, New said, “I venture to suggest that GP 2023 will not be the last in the series!”
Giant Prawn 2023 (GP 2023) was a unique conference on the farming of freshwater prawns of the genus Macrobrachium. It was held in November 27-29 2023 in Bangkok with the theme “Another Giant Leap for Sustainability”.
Robins McIntosh, Executive Vice President, Charoen Pokphand Foods (CPF), Thailand discussed the potential of the freshwater prawn industry as a global competitor to the marine shrimp. Back in the 1970s, corporate interest in Macrobrachium rosenbergii farming was spurred by its phenomenal growth - 110g in 6 months. Later came the knowledge that male prawns grew faster and the effect of density. “Farmers started to select for all-males. In terms of ratio, 10% females in the population were ideal,” said McIntosh.
“In Thailand and the region, the Macrobrachium has the native culinary advantage which the marine shrimp does not have,” said McIntosh. However, the head comprises 60% of the prawn and when frozen, the high enzyme levels destroy the tail muscle.
Giant Prawn 2023 (GP 2023) was a unique conference on the farming of freshwater prawns genus Macrobrachium. It was held in November 26-29 2023 in Bangkok with the theme Giant Leap for Sustainability ” .
Dedicated groups of farmers and hatchery operators as well as scientists welcomed the return of this event. Aside from attracting several seasoned players and newbies in the industry, from researchers to farmers as participants and speakers, GP2023 also saw the involvement of several pioneers in giant freshwater prawn farming: namely Robins MacIntosh, Patrick Sorgeloos, Soe Tun and William Collis.
Dedicated groups of farmers and hatchery operators as well as scienMsts welcomed the event. Aside from aNracMng several seasoned players and newbies in the industry, from to farmers as parMcipants and speakers, GP2023 also saw the involvement of several pioneers giant freshwater prawn farming: namely Robins MacIntosh, Prof Patrick Sorgeloos, Soe Name.
Dr Krishna R. Salin, Chair, Aquaculture Program, Asian Institute of Technology (AIT), Thailand is the driving force behind these giant prawn conferences, together with Michael New, OBE. There have been several of them held in 1990, 2003, 2011, 2017 and 2019 in venues including Bangkok, Shanghai and Kochi. GP2023 was organised by AIT jointly with the Shanghai Ocean University, China, led by Xuxiong Huang and the Department of Fisheries, Thailand (DoF)
Krishna R. Salin, Chair, Aquaculture Program, Asian InsMtute of Technology (AIT), Thailand driving force behind these giant prawn conferences, together with Michael New, OBE. been several of them held in 1990, 2003, 2011, 2017 and 2019 in venues including Bangkok, Shanghai and Kochi. GP2023 organised by AIT jointly with the Shanghai Ocean University, led by and the Department of Fisheries, Thailand (DOF).

The green water hatchery technology became the basis of the boom in the Asian industry. In the 2007-2008, MrNV affected production. Since 2014, with improved stocks, the industry recovered and increased by 6%. Production has improved but not at a high rate. Comparing the prawn and marine shrimp, growth in marine shrimp farming with domestication and SPF broodstock is an advantage over the prawn where these concepts are new. McIntosh reckoned that with domestication and SPF broodstock, the freshwater prawn can make a significant contribution to annual production. However, the cannibalistic behavioural interaction is a challenge. The incentive to farm the prawn is that it grows to 20g in 55 days versus 120 days for the vannamei shrimp. “If we can increase growth to 50g in the same time, it will be a significant contribution to the prawn industry. ”
The most significant technology advancement since 2012 is monosex male populations. “Monosex post larvae is available in Thailand since 2015. Monosex alone significantly improved hatchery survival to up to 63% and with biofloc, survival is higher at 75%.”
There is a long history meet. Forty-three years ago, Michael New, as FAO Manager organised the first Giant Prawn conference in 1980 with DOF. p editor for the publicaMon of papers from this event. In to the aNendees, New said, “I venture to suggest that GP 2023 will not be the last in the
McIntosh said that Ecuador’s shrimp farming should be familiar to prawn farmers - large ponds, low density and nursery phase. Similarly, following the example of Thailand, the grow-out technology to increase production is with a nursery to produce 4g juveniles and grow-out in polyculture with monosex all-male prawn and vannamei shrimp. Target prawn sizes are 57g. The message was, “The opportunity is the high value with domestic market. This is a huge market to be tapped. We need to continue to improve genetics, distribute clean post larvae, deploy aeration and autofeeders etc to be efficient.”
Robins McIntosh, ExecuMve Vice President, Charoen Pokphand Foods (CPF), Thailand potenMal of the freshwater prawn industry as a global compeMtor to marine shrimp. Back 1970s, corporate interest in Macrobrachium rosenbergii farming was spurred by its phenomenal growth - 110g in 6 months and knowledge that it could be grown in hatcheries . Later
Back in 1978, Dr Patrick Sorgeloos, Emeritus Professor, Ghent University, Belgium had his first experience with M. rosenbergii in Chachoengsao province with Michael New. In his presentation, he discussed the need for new microbial management systems in crustacean farming. Key to successful aquaculture is predictability and cost effective availability of high quality post larvae and fingerlings, but unfortunately attention has been on number and to produce post larvae cheaply rather than on quality.
There is room for improvement in managing Artemia. “The practices today are by far not as good as they were 2030 years ago. Industry has forgotten the basics. Biology is crucial as well as water quality, temperature, light, pH, Vibrio loads and biosecure Artemia.” Sorgeloos explained that often hatcheries prefer instar II because of the higher biomass but more important is the nutritional value. On dry weight basis, Instar II is lower in nutritional value and is associated with high Vibrio loads. “Therefore, there is a need to adopt standardised protocols. A practice not seen in Asia, but common in Europe and Latin America, is cold storage of instar I Artemia over a period.” Sorgeloos announced that more information will be in the manual to be published.
Sorgeloos concluded, “It is time for some new recommendations for good aquaculture practices at the hatchery. We still need more knowledge on the role and the possible pathogenicity of the bacteria.”
In his overview on production at the global level, Salin said that the production is focussed on two species, M. rosenbergii (Giant river prawn) and Macrobrachium nipponense (Oriental river prawn), the latter mainly in China. These two species contributed 2.6% (294,000 tonnes) and 2.0% (228,000 tonnes), respectively, of the global crustacean production (FAO, 2023), but the market value of the production in 2020 was USD2.29 billion (OECD 2023).
While there have been some persistent challenges, such as low larval production with late metamorphosis failures and more intensive culture systems causing size differences in growth, the adoption of innovative farming techniques and improved disease identification appear promising. “Increasingly, we see more polyculture with marine shrimp and fish (such as tilapia). While polyculture proves profitable, I question its sustainability and the potential implications of unregulated practices. Biofloc and probiotics can streamline the hatchery and grow-out but require more research,” said Salin. In contrast, there is the issue of water quality leading to problems of off-flavour with cyanobacteria toxins in ponds fertilised by using organic manure, as well as the detection of water-borne pollutants in exported prawn products.
Sorgeloos concluded, “It is Mme for some new recommendaMons for good aquaculture pracMces at the hatchery. We sMll need more knowledge on the role and the possible pathogenicity of the bacteria.”
On feeding frequencies, he asked industry to consider retention time of food particles as more frequent feedings will result in less chances for the bacteria to develop and a further deterioration. The focus was also on seawater ionic composition and his message was to start with quality seawater or use a technique of mixing 120g/L brine to make up seawater.
In biosecurity, key is to avoid the presence of obligate bacteria. Disinfection of the water eliminates all bacteria. However, upon refilling and restocking, there is a succession of a huge diversity of bacteria but a proliferation of r-strategist (mainly opportunistic Vibrio) over that of k-strategist (other neutral/beneficial bacteria). “After disinfection and stocking the larvae, Vibrio will colonise and depending on the amount of nutrients present, may reach such levels as to switch on virulence by quorum sensing or by phenotypical switching. The balance between r-strategists and k-strategists determines the risk for bacterial interference which is not easily predictable.
Salin updated on the progress with certification of giant prawn farms, focussing on environmental and social responsibility, food safety and animal welfare. In Bangladesh, one farm is ASC-certified and 7 farms have BAP certifications. In India, organic farming of M. rosenbergii, with rice, is profitable, according to a 2013 article. It was started by MPEDA in the wetlands and took four years to complete the process towards organic certification. When sold in supermarkets in Germany, there was a 15-20% price premium for organic-certified prawns. However, the project faced a setback mainly due to the lack of an appropriate market for organic rice. “Although profitable, the challenge faced was a sustained premium market.”

Figure 1. Global produc8on of the Macrobrachium rosenbergii (Source: FAO 2023). Source: Krishna R Salin, Title to add. Source: SOFIA 2022 (hNps://www.fao.org/3/cc0461en/cc0461en.pdf )

There are innovations in the improvement of genetic and genomics producing SPF broodstock, easier sex reversal technologies with gene silencing for mass production of all-male and all-female prawns and silencing of MIH and VIH on ovarian maturation while considering the welfare of animals. Biofloc, functional feed additives, and probiotics should have a larger role in farming since they have been proven to increase growth rate and survival. “With improved biosecurity, we can work to prevent disease outbreaks,” added Salin.
Dr Malasri Khumsri, Head of Aquaculture Research and Business Group, DoF discussed the “Resurgence of Giant Prawn Industry in Thailand” and its challenges and opportunities. Production from aquaculture has been increasing since 2014 and in 2022, increased 3 % to 44,756 tonnes. With more production in the first 6 months in 2023, the estimate for 2023 is an increase of 2.4% to 45,815 tonnes, valued at THB9,649.9 million (USD272.5 million). Out of the 14,000 farms 2,274 (16%) are certified with Good Aquaculture Practices (GAP) standards. Most of them are in the central region, including Nakhon Pathom, Ratchaburi, Chachoengsao, Kalasin and Suphanburi provinces.
However, market demand has decreased due to the economic situation. “In the first 6 months of 2023, average prices of live male prawns dropped 4.0-9.1% and that for female prawns at 0.7-5.3% compared to the same period in 2022. In July 2023, prices for size 8-10/kg dropped to below THB350/kg (USD9.9/kg). “In general, prices are unstable and markets limited. Demand is high during festivals such as the New Year and Songkran festivals. Farm standards are needed for exports. The Fry Movement Document (FMD) from DoF is voluntary for farmers but if they do not comply to the recommendations, they lose export opportunities.”
Thailand imports mainly fresh and chilled prawns from India, Bangladesh, Myanmar and Sri Lanka. It exports mainly frozen prawns to Sri Lanka, China, US and Malaysia. There are also exports and imports of broodstock. In terms of challenges, Malasri listed: low and unstable post larvae quality, diseases, broodstock management, high production costs, and water shortage and pollution. At the grow out level, challenges include low survival rate and slow growth, inadequate supply of post larvae, and low
and unstable feed quality. Costs of inputs, such as for feeds, electricity and wages are high.
New trends in Thailand include the hatchery production of all-male post larvae and in grow-out, there is the all-male prawn production and polyculture with marine shrimp to reduce risk and ensure better profits. (Related articles in issue January/February 2024 on commercial production of all-male giant freshwater prawn post larvae in Thailand, pp13-17. https://bitly. ws/3fMHd; Polyculture of marine shrimp and giant freshwater prawn in Chachoengsao Province, pp 2224; https://bitly.ws/3fMHD).
There is a nursery phase to increase survival rate and reduce culture period to only 4 months and raise 2-3 crops/year. DoF, universities, NSTDA and the private sector are working together to further advance the prawn industry. It works well that the giant prawn is recognised as an economic species.
There are plans for the resurgence of the giant prawn culture in Thailand and strategies focus on: marketing; production optimisation; strengthening of farmers with increased knowledge; use of appropriate technology to reduce COP; good quality post larvae and research technologies to have high quality PL; new strains with high survival rates and fast growth; nurseries for PL for 2 - 3 months; and then grow-out for 3 months to target size 20/kg. “We ask the farmer to change and adopt new technology.”
China: Greenhouse for three batch culture
Dr Julin Yuan, Deputy Director of ZIFF, College of Fisheries and Life Science, Shanghai Ocean University focussed on the farming of the endemic and small adult body M. nipponense, although three species are commercially farmed, including M. rosenbergii which was introduced from Japan and Macrobrachium hainanense in south China. In 2021, China produced 171,263 tonnes of M. rosenbergii and 224,413 tonnes of M. nipponense. However, peak production of the latter species was in 2017 at 240,739 tonnes.
There are three culture models in the farming of M. nipponensis: monoculture and polyculture in ponds; and integrated culture in rice fields. Challenges in farming include, wastewater eutrophication from post larvae production ponds, inbreeding in ponds resulting in poor commercial sizes and degraded germplasm resources. Feeds do not meet nutritional requirements because of incomplete studies. For a sustainable development of the industry in China, Yuan said, “We need to develop environmentally friendly culture models, produce monosex post larvae, both all-male and all-female for farming and hybridisation to produce sterile strains.”
With regards to M. rosenbergii, Hu Zhou in Zhejiang province is the leading supplier of post larvae with 60 hatcheries producing 62.5% of post larvae in China. The main farming areas are Guangdong, Jiangsu and Zhejiang. Production has had its ups and down with the latest challenge in 2023 with iridescent virus disease. Prior to
this, in 2013 it was the iron prawn syndrome which brought production down to 117,402 tonnes from 144,467 tonnes in 2011.
Yuan described the recent farming technology involving a greenhouse for three-batch culture with heating which can produce all year round to yield 12 tonnes/ha. In contrast, a pond system can only produce 4.5 tonnes/ha over the months of May to October. Other systems are polyculture of rice/prawn and prawn/mitten crab.
“The story of the giant prawn in Bangladesh is that it is an untapped goldmine,” said Dr Kabir Chowdhury, Sales Director – South Asia of Jefo Nutrition Inc., Canada, and the founder of Maverick Innovation, a recently established regional research service provider.
Bangladesh is the second largest producer of farmed giant prawn at 58,680 tonnes in 2021 compared to only 34,862 tonnes in 2015. Local consumption was almost 90% of the production in 2021-2022, a mere 5,772 tonnes were exported. Potentially, a large untapped export market and strong domestic demand have made giant prawn a choice species for economic development of Bangladesh through aquaculture.
Currently, the total farming area is 72,000ha, which Kabir said gives an opportunity for expansion. Moving forward, the hatchery segment could take advantage of recirculating aquaculture system (RAS) technology to avoid waterborne diseases. Besides, establishing a low-cost low-energy intermediary RAS-based nursery systems could open new opportunities for small holders in rural Bangladesh. ”
In addition, genetics development could look at identifying and selecting suitable local strains, and work at domestication (F1-F2-F3) and mono-sex production. The grow-out segment could look at improved extensive/semiintensive systems, polyculture systems, seasonal farming, and feed development.
Kabir concluded, “Improved genetics, adoption of lowcost nursery technology, monosex farming together with
improved production technology could help to double the production of giant prawn in Bangladesh in the next five years.”
The team from Can Tho University led by Dr Tran Ngoc Hai, noted that in 2010, in the Mekong Delta the area under prawn farming was 13,527ha with a production of 6,937 tonnes. In 2023, it has reached to nearly 80,000ha. Production was 29,000 tonnes of almost allmale populations. In terms of yields, it was 558kg/ha/ crop in brackishwater ponds and 717kg/ha/crop in 2022. In brackishwater, it was all-male culture at 82% and the balance by mixed sex culture. In freshwater, the ratio is 55.3: 44.7 (mixed sex: all-male culture).
In a survey of 150 farms, the team reported the following systems:
• alternative rice-prawn culture in freshwater with prawn culture during the flood season and stocking at 11 PL/ m2 to yield is 1,100kg/ha.
• integrated rice-prawn culture in brackish water with shrimp culture in the dry season and prawn cum rice culture in the wet season at low salinity or freshwater, stocking at 1.5 PL/m2 and yield is 110kg/ha.
• alternative rice-prawn culture in brackish water with marine shrimp culture in the dry season and prawn culture in the wet season at low salinity or freshwater with stocking at 5.2 PL/m2 and yield is 362kg/ha.
Can Tho University has found that the alternative culture system produced the best results. The stocking density was 6 PL/m2 with the post larvae kept in the nursing pond for 60 days and fed 42% CP pellets. Yield was 660kg/ha of 52g prawn.
Another project was on using biofloc technology for post larvae production. Findings indicated that sugar was the best carbon source to be added from PL4. Survival rate was 56-60%, and yields were up to 38,083 PL/m3 when the larvae stocking density was 60 ind/L. Good and stable results led to the adoption by commercial hatcheries in the country. Prawn culture is important in Vietnam and the Ministry of Agriculture and Rural Development has targeted a production of 50,000 tonnes by 2025.


giant prawn producing state followed by West Bengal and Maharashtra. The decline in production was attributed mainly to poor quality post larvae and therefore low survival rates, leading to poor profitability. “Disease outbreaks were noda virus and bacterial diseases especially in Nellore. The high production potential of vannamei shrimp and pangasius, lured farmers away from prawn farming,” added Bindu.
Culture practices range from polyculture with Indian major carps at low stocking density of 5,000-15,000/ ha, monoculture and male monosex culture with manual selection and stocking at 30,000/ha and reservoir stocking of juveniles of 2-5g.
Thay Somony, Director, Department of Aquaculture Development of Fisheries AdministraMon
Thay Somony, Director, Department of Aquaculture Development of Fisheries Administration (FiA), Cambodia described how FiA started with a project to culture the giant prawn with rice in two districts in Takeo province located in the lower Mekong Delta with three farmers. The culture was over 8 months and prawns grew to size 8/kg or 123g and stocking was 7 PL15/m 2. This was successful and the net return was 10 times higher than just rice culture. “We concluded that rice-prawn culture should be promoted in the Lower Mekong Delta of Cambodia in order to increase farmer’s income.”
There was a genetic improvement program conducted by ICAR-CIFA in 2007 using wild broodstock from Gujarat, Kerala and Odisha. A genetically improved (GI), fast-growing strain of M. rosenbergii in collaboration with WorldFish, Malaysia was produced. ICAR-CIFA then continued an inhouse project from 2014-2021 and registered a fast-growing strain, CIFA GI Scampi. The Government of India then approved a selective breeding program from 2021-2024. In her presentation, Bindu described in detail the program from 2007 as well as pond trials.
Cambodia described how FiA started with a project to culture the giant prawn with districts in Takeo province located in the lower Mekong Delta with three farmers. over 8 months and prawns grew to size 8/kg or 123g and stocking was 7 PL15/m and the net return was 10 Mmes higher than just rice culture. Prawns were sold concluded that rice-prawn culture should be promoted in the Lower Mekong Delta order to increase farmer’s income.”
The project expanded in 2020-2023 with the involvement of 20 families. Production was 7 tonnes.
“Takeo prawn is a well-known and a high-value aquatic product in the country, it sells at around USD35-40/ kg for first-grade products, USD20/kg for secondgrade and USD10-15/kg for third-grade products.”
Thay outlined some future directions. Among them, to improve knowledge, experience, and research skills of aquaculture for FiA officers; to increase the production capacity of both state and privately-owned hatcheries to meet the seed demand for grow-out culture; and to study extensively the rice-prawn culture technology.
The dissemination of CIFA GI Scampi was through five multiplier hatcheries. A reported yield from monoculture with post larvae supplied by BKMN Aqua hatchery was 2 tonnes/ha in 8 months. The future plans for this CIFA GI Scampi program include increasing the number of multiplier hatcheries; close monitoring of multiplier scampi hatcheries to ensure the purity of GI scampi; and operating the selective breeding program through a public, private partnership. Bindu expects a good future with the giant prawn, “The plan is to scale up production to 30,000 tonnes. ”
The project expanded in 2020-2023 with the involvement of 20 families. ProducMon “Takeo prawn is a well-known and high-value aquaMc product in the country, it 40/kg for first-grade products, USD20/kg for second-grade and USD10-15/kg for products.” Thay outlined some future direcMons. Among them were: to improve experience, and research skills of aquaculture for FiA officers; to increase the producMon both state and privately-owned hatcheries to meet the seed demand for growstudy extensively the rice-prawn culture technology and innovaMon.
“India’s production in 2021 was 18,086 tonnes (FAO, 2023), which was a drop from the peak in 2005 at 42,820 tonnes,” said Dr Bindu R. Pillai, Principal Scientist at ICAR-Central Institute of Freshwater Aquaculture, Bhubaneswar, Odisha. Andhra Pradesh is the leading
In Malaysia, 3,000 tonnes of freshwater prawns are consumed annually with 90% imported to meet local demand. Locally known as “Udang Galah”, the prawn is popular in most seafood restaurants. The demand for large-sized prawns has raised prices to as high as MYR90 per kg (USD21.50/kg).
Giva Kuppusamy, CEO and Founder, GK Aqua estimated a production of around 700 tonnes in 2023. The business model of this startup covers the supply chain from genetics, hatchery, nutrition and health, farming and

“ tonnes (FAO, 2023), which was a drop from at 42,820 tonnes, , Principal ScienMst ICAR- Central InsMtute Aquaculture, Bhubaneswar, Odisha, India. Andhra Pradesh is the leading giant prawn state followed by West Bengal and Maharashtra. The decline in producMon was poor quality post larvae and there , leading to poor profitability outbreaks were noda virus and bacterial diseases especially in Nellore. The high of vannamei shrimp and pangasius, lured farmers away from prawn farming,” added Culture pracMces range from polyculture with Indian major carps at low stocking 15,000/ha, monoculture and male monosex culture with manual selecMon and


marketing. He has started contract farming called the Malaysian Udang Galah Aquaprenuers (MUGA) which targets entrepreneurs. The Malaysian government provides the land resources, GK Aqua, the technical know-how and banks, financing. Fund raising continues with a target of USD8 million by 2024 to expand MUGA to 150ha.
The panel discussing the resilience of the Macrobrachium industry also touched on some market challenges. McIntosh saw a growth potential since there is large demand in the domestic market. When producers target export markets, they need to accept that prices will unlikely match those in local markets, as most importing countries have no cultural love for the giant prawn. Similar to the white shrimp in Thailand, as volumes increase there will be a larger market acceptance.
Malasri added that Thailand has learnt a lot with exporting the prawn to Asian countries. There are problems with the transport of live prawns. More challenging are the different import requirements but

she said that it is difficult to have a common standard, although the farming methods are similar. She added that farms also need to improve on culture practices. Sorgeloos added that there is a big difference with exports to the region and to the rest of the world. He saw the potential of large prawn to substitute the lobster but more crucial is the freezing technology to minimise the difference between fresh and frozen prawn.
Admittedly, yields from prawn farming cannot reach that of intensive marine shrimp and may be at the 3-4 tonnes/ ha level. With all-male prawn, yields are much higher with the same stocking density and area. McIntosh said that any species can double the yield by increasing the number of crops and improve growth rates through genetics.
“However, with the giant prawn, the market is focussed on size and therefore, all-male culture. If we work at increasing growth rate, we target the premium market. Consumers pay for celebratory food such as large prawn. To have more production, technology will be needed to reduce the cost of production.”



SyAqua, a pioneering leader in shrimp breeding announced that that Dr Craig L. Browdy is its new Chief Technology Officer (CTO). With his extensive experience and expertise in marine shrimp research spanning over four decades, Browdy is set to lead SyAqua’s cutting-edge research initiatives and drive innovation in the field of aquaculture.
Fred Kao, CEO at SyAqua said, “We are thrilled to welcome Dr. Craig L. Browdy to the SyAqua team as our Chief Technology Officer,” adding “his unparalleled expertise and track record of innovation in aquaculture research will be invaluable as we continue to push the boundaries of shrimp breeding and sustainable aquaculture practices.”
Browdy’s illustrious career includes serving as the President of the World Aquaculture Society and conducting groundbreaking research in marine shrimp reproduction and genetics. He played a pivotal role in the development of genetically improved specific pathogen-free shrimp as part of the USDA-funded US Marine Shrimp Farming Program Consortium during the 1990s. More on this appointment https://bitly.ws/3fUYF


To lead the growth strategy for the Asian markets, BioMar has appointed the experienced animal nutrition and aquaculture profile Cedric van den Bossche as Vice President for the Asia division, which today comprises the business units in Vietnam and China. Van den Bossche has more than 15 years of experience building up businesses in the Asian markets, mainly working in general management roles for ADM and NEOVIA in China, Indonesia, and India. After a transition period he will take over from Francois Loubere, who has decided to retire after more than 30 years in BioMar.
As VP for Asia, he will be working out of China, developing the product portfolio and the market strategies for the Asian markets together with the local teams. He will take lead looking into new opportunities for developing BioMar across Asia.
Carlos Diaz CEO BioMar Group, said, “I am truly happy welcoming Cedric as a part of our executive management. We have during the last years built a solid position in the Chinese market, created a strong global market position within the shrimp feed segment, and started the penetration of the Vietnamese market. There is huge potential for further growth in Asia and I am sure Cedric is bringing both the right entrepreneurial spirit and the solid management experience we need to accelerate the further growth in the region.” More on this appointment https://bitly.ws/3fUYd
For advertising/article contributions and guidelines contact: zuridah@aquaasiapac.com





Chart Your Course to Tomorrow: Join the 2024 Taiwan Smart Agriculture Week & Int’l Aquaculture Expo – Dive into the S.M.A.R.T. New Realm!
Chart Your Course to Tomorrow: Join the 2024 Taiwan Smart Agriculture Week & Int’l Aquaculture Expo – Dive into the S.M.A.R.T. New Realm!
Amidst the global wave of digital transformation in agriculture and fisheries, the 2024 Taiwan Smart Agriculture Week and Int’l Aquaculture & Fisheries Expo provides a prime opportunity for manufacturers to engage in international trade. This event serves as a premier platform to showcase innovative products and foster business connections, guided by its unique S.M.A.R.T. (Sustainability, Market, Advance, Resilience, and Technology) strategy.
Chart Your Course to Tomorrow: Join the 2024 Taiwan Smart Agriculture Week & Int’l Aquaculture Expo – Dive into the S.M.A.R.T. New Realm!
new international markets for your products and services. Beyond a conventional exhibition, this platform represents a convergence of industryleading, forward-looking technologies. We invite you to present innovative technologies that set trends and foster in-depth engagement with peers from around the world.
Resilience: Your participation will showcase your enterprise’s capacity to address global challenges like climate change. Showcasing the development of robust and adaptive production systems will position your enterprise as a beacon of leadership in the industry.
Amidst the global wave of digital transformation in agriculture and fisheries, the 2024 Taiwan Smart Agriculture Week and Int’l Aquaculture & Fisheries Expo provides a prime opportunity for manufacturers to engage in international trade. This event serves as a premier platform to showcase innovative products and foster business connections, guided by its unique S.M.A.R.T. (Sustainability, Market, Advance, Resilience, and Technology) strategy.
Amidst the global wave of digital transformation in agriculture and fisheries, the 2024 Taiwan Smart Agriculture Week and Int’l Aquaculture & Fisheries Expo provides a prime opportunity for manufacturers to engage in international trade. This event serves as a premier platform to showcase innovative products and foster business connections, guided by its unique S.M.A.R.T. (Sustainability, Market, Advance, Resilience, and Technology) strategy.
Amidst the global wave of digital transformation in agriculture and fisheries, the 2024 Taiwan Smart Agriculture Week and Int’l Aquaculture & Fisheries Expo provides a prime opportunity for manufacturers to engage in international trade. This event serves as a premier platform to showcase innovative products and foster business connections, guided by its unique S.M.A.R.T. (Sustainability, Market, Advance, Resilience, and Technology) strategy.
Sustainability: Join to showcase groundbreaking solutions that pave the way for industry-wide sustainable development. Your participation is a catalyst for inspiring the entire supply chain to explore avenues for environmental, economic, and social sustainability. This positions your brand and products as trailblazers in driving a global transformation towards sustainability in the agrifisheries sector.
Sustainability: Join to showcase groundbreaking solutions that pave the way for industrywide sustainable development. Your participation is a catalyst for inspiring the entire supply chain to explore avenues for environmental, economic, and social sustainability. This positions your brand and products as trailblazers in driving a global transformation towards sustainability in the agri-fisheries sector.
Technology: Showcase the latest technological applications, spanning from intelligent machinery to big data analytics. Your cutting-edge technology is poised to inspire the audience and propel the entire agri-fisheries sector into a new digital era. Your participation is not just a contribution; it adds splendour to the exhibition, your innovations are instrumental in leading industry development, and your stories serve as inspiration to all attendees.
Sustainability: Join to showcase groundbreaking solutions that pave the way for industrywide sustainable development. Your participation is a catalyst for inspiring the entire supply chain to explore avenues for environmental, economic, and social sustainability. This positions your brand and products as trailblazers in driving a global transformation towards sustainability in the agri-fisheries sector.
Sustainability: Join to showcase groundbreaking solutions that pave the way for industrywide sustainable development. Your participation is a catalyst for inspiring the entire supply chain to explore avenues for environmental, economic, and social sustainability. This positions your brand and products as trailblazers in driving a global transformation towards sustainability in the agri-fisheries sector.
Market: Seize the opportunity to showcase your advanced solutions directly to global buyers on this platform. The strategic marketing and business matchmaking services are designed to elevate your brand visibility and open doors to
Market: Seize the opportunity to showcase your advanced solutions directly to global buyers on this platform. The strategic marketing and business matchmaking services are designed to elevate your brand visibility and open doors to new international markets for your products and services. Beyond a conventional exhibition, this platform represents a convergence of industry-leading, forward-looking technologies. We invite you to present innovative technologies that set trends and foster in-depth engagement with peers from around the world.
Both the 2024 Taiwan Smart Agriculture Week and Int’l Aquaculture & Fisheries Expo are excited to collaborate and shape the S.M.A.R.T. future of agri-fisheries with you. More information: https://www.taiwanagriweek.com/en/. Contact Rae Chang rae_chang@myexhibition.com.tw
Market: Seize the opportunity to showcase your advanced solutions directly to global buyers on this platform. The strategic marketing and business matchmaking services are designed to elevate your brand visibility and open doors to new international markets for your products and services. Beyond a conventional exhibition, this platform represents a convergence of industry-leading, forward-looking technologies. We invite you to present innovative technologies that set trends and foster in-depth engagement with peers from around the world.
Market: Seize the opportunity to showcase your advanced solutions directly to global buyers on this platform. The strategic marketing and business matchmaking services are designed to elevate your brand visibility and open doors to new international markets for your products and services. Beyond a conventional exhibition, this platform represents a convergence of industry-leading, forward-looking technologies. We invite you to present innovative technologies that set trends and foster in-depth engagement with peers from around the world.
Resilience: Your participation will showcase your enterprise's capacity to address global challenges like climate change. Showcasing the development of robust and adaptive production systems will position your enterprise as a beacon of leadership in the industry.
Resilience: Your participation will showcase your enterprise's capacity to address global challenges like climate change. Showcasing the development of robust and adaptive production systems will position your enterprise as a beacon of leadership in the industry.
Resilience: Your participation will showcase your enterprise's capacity to address global challenges like climate change. Showcasing the development of robust and adaptive production systems will position your enterprise as a beacon of leadership in the industry.
Technology: Showcase the latest technological applications, spanning from intelligent machinery to big data analytics. Your cutting-edge technology is poised to inspire the audience and propel the entire agri-fisheries sector into a new digital era. Your participation is not just a contribution; it adds splendor to the exhibition, your innovations are instrumental in leading industry development, and your stories serve as inspiration to all attendees.
Technology: Showcase the latest technological applications, spanning from intelligent machinery to big data analytics. Your cutting-edge technology is poised to inspire the audience and propel the entire agri-fisheries sector into a new digital era. Your participation is not just a contribution; it adds splendor to the exhibition, your innovations are instrumental in leading industry development, and your stories serve as inspiration to all attendees.
Technology: Showcase the latest technological applications, spanning from intelligent machinery to big data analytics. Your cutting-edge technology is poised to inspire the audience and propel the entire agri-fisheries sector into a new digital era. Your participation is not just a contribution; it adds splendor to the exhibition, your innovations are instrumental in leading industry development, and your stories serve as inspiration to all attendees.









larvi 2024 8th fish and shellfish larviculture symposium
l arvi 2024 will be held from September 9-12, 2024, in Ostend, Belgium. This is the 8th Fish & Shellfish Larviculture Symposium.
Closing the life cycle of aquaculture species of economic importance is critical for the ultimate success of aquaculture. Predictable and cost-effective availability of high-quality fry, fingerlings, postlarvae, seed, spores, etc. remain key to a successful aquaculture venture. Knowledge generated at many different levels can further increase the success of the sector.
2024. Bringing together European and non-European stakeholders, once again the latest progress in academic research and in the production sector will be reviewed, problems identified and avenues for future collaboration explored.
larvi 2024 8th fish and shellfish larviculture symposium

Considerable progress is being made in knowledgebased insights on, for example, the genetic make-up of the broodstock, steering the ontogeny, the importance of first feeding, steering host microbial interactions and its immunological consequences and automation. Research in these fields is increasingly supported and stimulated by a variety of novel and sophisticated techniques such as omics and artificial intelligence tools. They generate an unprecedented and often fascinating insight into biological processes.
Tentative programme
Session I. Broodstock management, maturation and spawning (zootechniques, nutrition, egg and larval quality, domestication, sperm quality, genetics, germplasm preservation, genomics and proteomics, transgenics and GMOs.)
Session II. Developmental biology and deformities (ontogeny, developmental biology, behaviour).
Session III. Larval nutrition (nutritional requirements, feeding schemes, live food, and its substitutes).
many different levels can further increase the success of the sector.
Session IV. Larviculture at commercial scale (culture systems, automation, environmental requirements, socio-economic aspects).
Considerable progress is being made in knowledge-based insights on, for example, the genetic makeup of the broodstock, steering the ontogeny, the importance of first feeding, steering host microbial interactions and its immunological consequences and automation Research in these fields is increasingly supported and stimulated by a variety of novel and sophisticated techniques such as omics and artificial intelligence tools. They generate an unprecedented and often fascinating insight into biological processes. Although they generally also raise new research questions, they stand for a major leap forward as compared to the empirical approach of a relatively recent past.
Session V. Disease prevention, pathogen control, biosecurity and health (prebiotics, probiotics, diseases and pathogens, microbial management, viral and bacterial challenge tests, vaccination, phage therapy).
Capitalising on the previous “larvi” symposia (in ’91, ’95, ’01, ’05, ’09, ’13, ‘17), the Aquaculture R&D Consortium of Ghent University, the Norwegian University of Science and Technology and SINTEF Ocean have joined again in the organising committee for “larvi’24” and are inviting the academic as well as the private sector to attend the 8th Fish and Shellfish Larviculture Symposium. Bringing together European and non-European stakeholders, once again the latest progress in academic research and in the production sector will be reviewed, problems identified and avenues for future collaboration explored.
Tentative programme
Capitalising on the previous “larvi” symposia (in ’91, ’95, ’01, ’05, ’09, ’13, ‘17), the Aquaculture R&D Consortium of Ghent University, the Norwegian University of Science and Technology and SINTEF Ocean have joined again in the organising committee for “larvi’24” and are inviting the academic as well as the private sector to attend tlarvi
Session I. Broodstock management, maturation and spawning (zootechniques, nutrition, egg and larval quality, domestication, sperm quality, genetics, germplasm preservation, genomics and proteomics, transgenics and GMOs.)
The first conference of the “International Artemia Aquaculture Consortium” IAAC (artemia.info) will be organised on September 9, 2024, at the same premises as the larvi conference. More information on the program for the IAAC event will be updated on the IAAC website. Detailed information will also gradually become available on the symposium at www.aquaculture.UGent.be/larvi
March 20-22
VietShrimp Camau City vietshrimp.net
April 23-25
Seafood Expo Global Barcelona, Spain seafoodexpo.com/global
April 26
International Aquaculture Conference Barcelona, Spain grains.org
May 27-31
XXI International Symposium on Fish Nutrition and Feeding(ISFNF) Puerto Vallarta, Mexico isfnf2024.com
June 5-6
Shrimp Aquaculture Conference Bali, Indonesia sac.pmindo.com
June 27-29
Shrimp Summit Chennai, India responsibleseafood.org
JULY 2-5
Asian Pacific Aquaculture 2024 (APA24) Surabaya, Indonesia was.org
August 14-15
TARS 2024: Finfish Aquaculture Bangkok, Thailand tarsaquaculture.com
August 21-23
VIETFISH 2024 vietfish.com.vn/en
August 26-30
AQUA24
Copenhagen, Denmark was.org

September 3-5
Global Shrimp Forum 2024 shrimp-forum.com
September 9-12
larvi 2024 Ostend, Belgium aquaculture.UGent.be/larvi
September 11-13
10th Aquaculture and Fisheries Expo Taiwan (IAFET) 2024 Taipei taiwanagriweek.com/en/
September 17-19
SPACE
Rennes, France space.fr
September 24-27
Latin American & & Caribbean Aquaculture 2024 Medellin, Colombia was.org
November 20-23
AFRAQ24 – Hammamet, Tunisia was.org















• No.16-18-20, DT743 Road, Song Than II Industrial Zone, Di An Ward, Di An City, Binh Duong Province, Vietnam
• Tel: +84-274-3790811 (Ext: 1711)
• Fax: +84-274-3790819
• Email: aquafeed@upvn.com.vn
